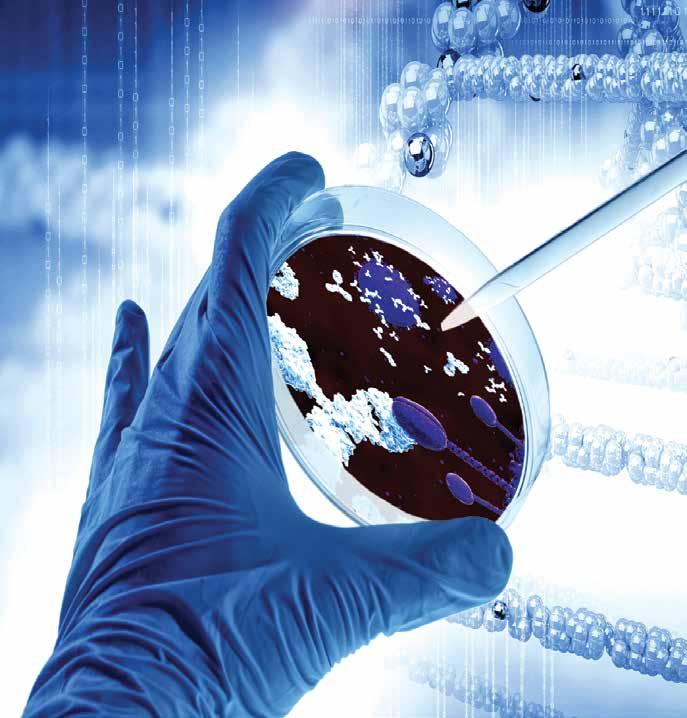
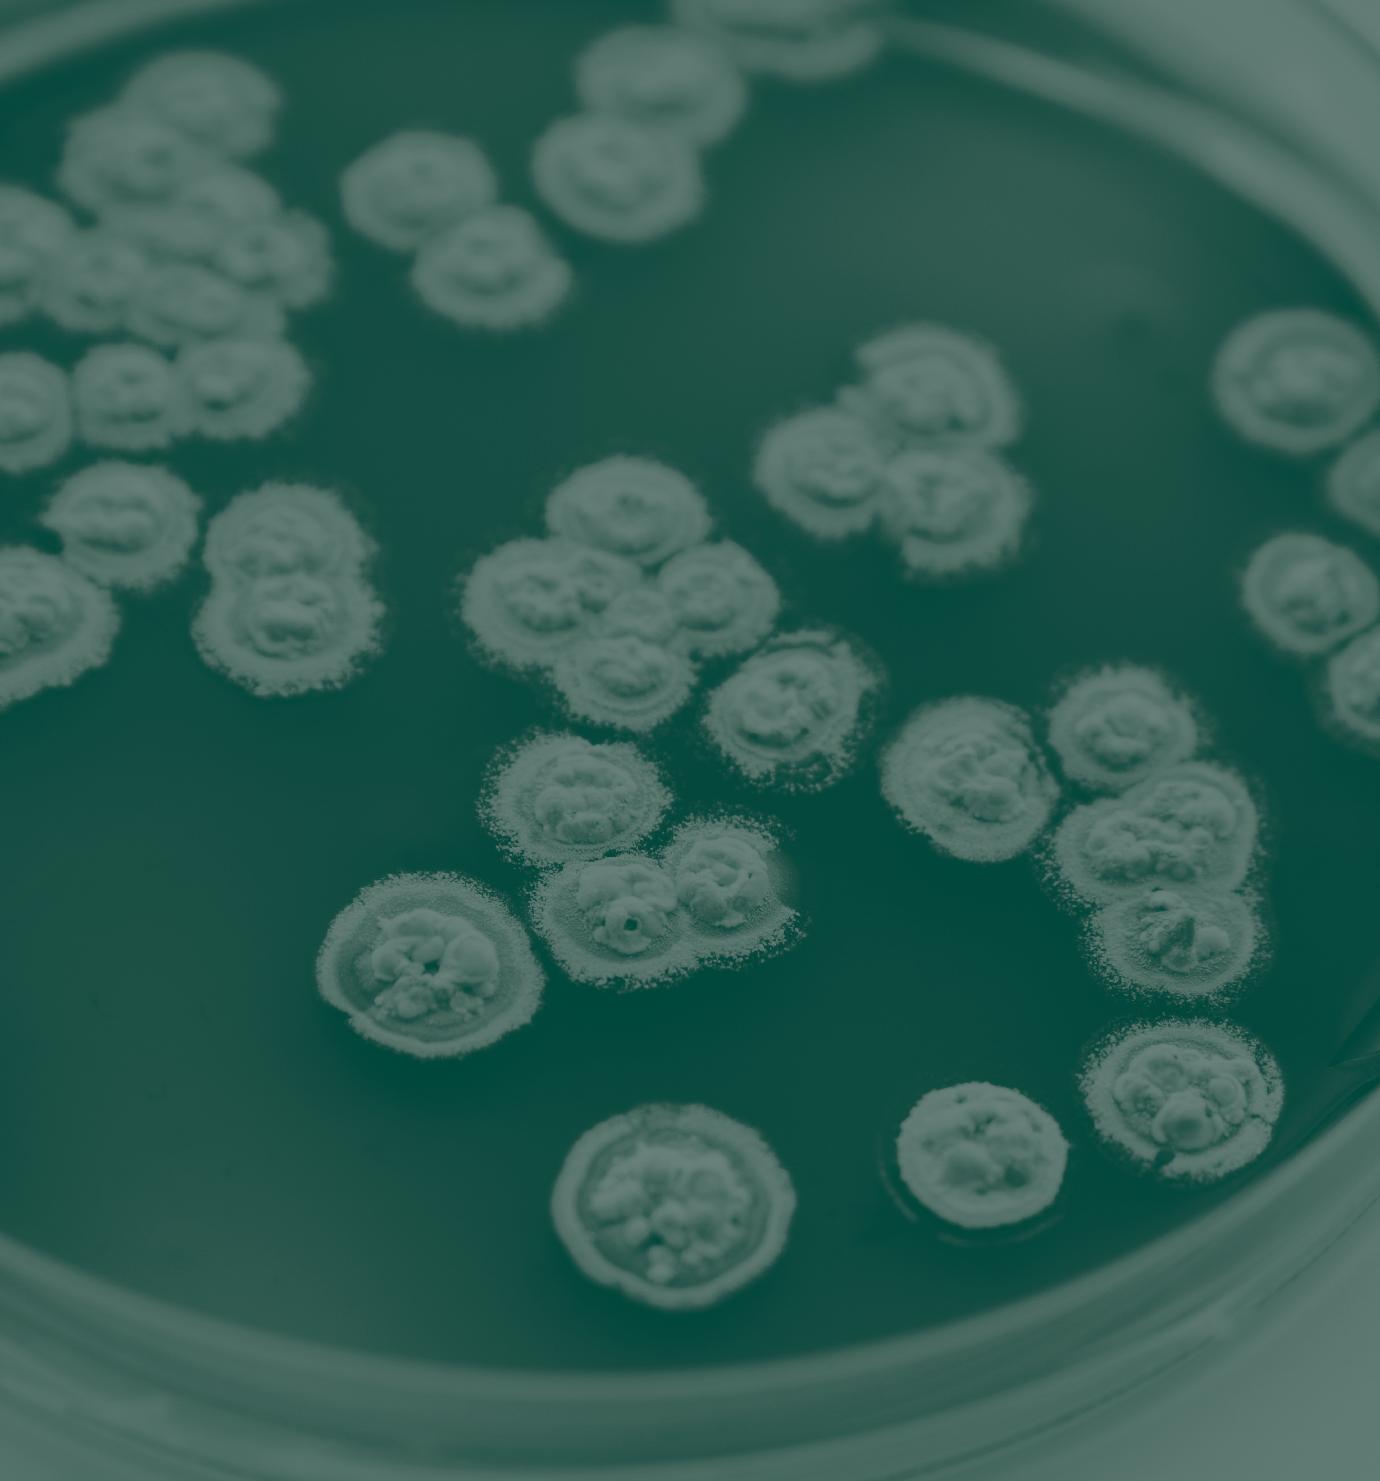

MILESTONES MEMORIES &


1925 to 2025


![]()


1925 to 2025


By Alan Knights
This book is dedicated to Croda’s wonderful global family, past and present, who created this story.



By Steve Foots Chief Executive Officer, Croda International Plc
To be CEO of this great company of ours at any time in our history would be an honour - but I feel particularly proud and privileged to hold this position as we reach this important milestone: our centenary. A hundred years that has taken us from a tiny family firm to a multibillion pound global organisation. A company that my predecessors and our first managing director, A P Wood, could hardly have dreamt of.
This book looks at some of the other milestones along our journey. To many, it will be fascinating to look back to the days when we didn’t just manufacture speciality ingredients, but we were amongst the leading suppliers of industrial paints, adhesives and printing inks, or perhaps somewhat surprisingly, that we were once the UK’s second largest producer of honey, the UK’s largest private label soap producer, as well as a leading manufacturer of road tars and bitumens.
At times, the road was bumpy and undoubtedly, we sometimes strayed off-track - but it was those occasional detours that led us to where we are now. That taught us a valuable lesson. To keep our eyes on the road and focus on what we do best: naturally derived speciality ingredients. And that’s because sustainability is enshrined in our history, right back to those early pioneering days of refining woolgrease to make lanolin. Today, Croda is synonymous with growth, sustainability and innovation, which can be summarised by Our Purpose: Smart science to improve lives™.
It is that Smart science that led to the development of Polawax back in the 1940s, a particularly effective emulsifier for cosmetic creams and lotions. Smart science that, at the turn of this century, led to the development of Matrixyl - an age-defying, anti-wrinkle active ingredient used in numerous cosmetic products, which is today almost as well known by the consumer as the end products themselves.
Smart science that harnesses the opportunities that biotechnology can offer the Home Care sector, such as a new generation of probiotic cleaning ingredients, providing safe and sustainable solutions by letting nature do the work.
Smart science that led to the creation of our lipid-based delivery systems for the first Covid-19 vaccines – technology that has contributed to protecting billions of lives globally. And then, as an innovation partner to major crop science companies, applying our expertise in delivery systems and seed enhancement to meet the sustainability challenges created by climate change.
Sustainability is enshrined in our history. “ “
But science can only be as smart as the people behind it. That’s why, above everything else, Croda is a people company, and our continuing success is a tribute to the many loyal, creative and visionary people who have contributed to our story. So, along with the milestones, this book also looks back at some of the memories and recollections, gathered over many years, from friends and colleagues. Some, sadly, are no longer with us, but we will always remember them, along with all the others, too many to mention, who together have created Croda’s wonderful, talented and quite unique global family to whom this book is dedicated. Here’s to the next hundred years!

1925
Croda is founded at Rawcliffe Bridge in Yorkshire, by Mr Crowe and Mr Dawe (hence the derivation of the name), to make lanolin from woolgrease. Crowe’s nephew, A P (Philip) Wood, is appointed Manager.
In October, the first order – three barrels of lanolin – leaves the factory by horse and cart to Rawcliffe station.
1928
Eric Cannon joins the Board of Croda. The Board, which comprised Crowe and Wood, Crowe’s son, Louis (who lived abroad and played little part in the running of the company) and Eric Cannon, remained unchanged until 1946.


Lanolin is a soft, yellow paste that is actually a refined form of wool wax, more commonly known as woolgrease, one of the most ancient of substances used by mankind.

The Goole Times is the weekly local newspaper for the inland port and town of Goole in East Yorkshire, England, UK. On 26 April 1925, it carried a brief announcement that the disused waterworks in the nearby village of Rawcliffe Bridge had been acquired by a director of the Crowe Manufacturing Company, with the possibility of a new company being formed ‘for the manufacture of grease’.
That new company was called Croda. The name was derived from the meeting of a man with money, Mr Crowe, and a man with an idea, Mr Dawe.
George Crowe, who was born in 1870, was a successful ship owner whose family had been based in Greece since the 1840s. He was approached by Dawe about the possibilities of manufacturing lanolin in England, and had decided to back the idea.
Lanolin is a soft, yellow paste that is actually a refined form of wool wax, one of the most ancient of substances used by mankind. Due to the physical nature of the product, the raw wool wax is more commonly referred to as woolgrease, a product that is surprisingly complex and quite unlike any other fat or oil.
Woolgrease is a protective lipid (fat) that is secreted onto the surface of sheep’s wool to protect the animal from weather and seasonal climatic changes. When the fleece has been removed from the sheep by shearing, and before it can be processed into woollen textiles, this fatty coating must be removed by washing, a process that was generally undertaken at a woollen mill.
It is important to note that as the wool has already been removed from the sheep, there is no harm to the animal during the subsequent processing. The resulting greasy water is then treated by various processes to recover the woolgrease, a yellow-brown fatty material with a characteristic smell.
During the late 19th century, processes were developed on the continent, mainly in Germany and Belgium, to refine woolgrease into lanolin, improving the colour and odour. It was used in a variety of industrial applications, such as leather dressing, textile waterproofing and rope lubricants.
By some means, Dawe had acquired or developed such a technology, and the new company acquired the old waterworks at Rawcliffe Bridge as its manufacturing site for the new venture. However, Dawe’s concept never worked properly, and the Crowe and Dawe partnership that had provided the name, did not survive many months. Undaunted, George Crowe was determined to continue with the venture, and called upon his nephew, A P (Philip) Wood, hiring him as manager at a salary of £7.00 per week.

George



In the period after the First World War, when young Wood had left school, he had been engaged in a number of projects for his Uncle George, none of which had been successful. However, this new assignment fired both of their imaginations, and Wood duly set off from his home in Greece to Yorkshire to get to work, arriving on 14 April 1925. His diary entry for that day read ‘First day at Rawcliffe Bridge. Inspected works.’ He was then just 22 years old. The shell of the main building needed little structural alteration. There was a house on the site, formerly occupied by the waterworks manager, in which Wood took up residence. He employed a Belgian chemist, Felix Desmedt, to supervise the process, all of which was watched with great interest by the local villagers.
Not yet married, Wood led a fairly sheltered life focusing mainly on his work, initially supervising the plant construction, and then actually making the first batches of lanolin. His evenings were mainly spent creating direct mail circulars using a battered old typewriter. It was the beginning of a philosophy he maintained throughout his life on the paramount importance of sales and marketing. Indeed, much of Croda’s early success was built on the use of direct mail to generate leads, often recruiting friends and family to address envelopes to carefully selected contacts compiled from trade directories.

Despite the failings of Dawe’s process to make lanolin, Wood persevered. His persistence combined with optimism were necessary traits in the gloomy days of the late 1920s. Eventually, he managed to acquire a workable process and on 20 October 1925, the first order of three barrels of lanolin left the works by horse and cart bound for Rawcliffe station. The workforce consisted of three men running the plant; the chemist, Felix Desmedt; a bookkeeper; a typist; and Wood himself.
By July 1925, Wood had married and was joined by his wife at the small house at the works. In May 1926, their son was born there, christened Frederick Ambrose Stuart Wood – later to become Managing Director and then Chairman of a business that Wood senior could hardly have dreamt of.
Trading conditions became very difficult and the original capital was running away at an alarming rate. By early 1927, the strain was beginning to tell on Wood, and his doctor advised him to move away from the house at the works. He and his family moved to Doncaster where they found themselves next door to a couple of a similar age, a Mr and Mrs Cannon. The two couples got on well and later that year, Eric Cannon joined the company as Secretary. Wood, who was somewhat introverted, was complemented by the more outgoing Cannon, who joined the Croda Board in 1928.
By the end of the decade, the business was virtually insolvent, sustained only by personal guarantees to the bank from Crowe and Wood. It was timely, therefore, that in 1929, fortune smiled…

The cashbook used by Mr Stones, the haulier, showing delivery of raw materials, packages and building materials. Note the entry for 20 October: ‘3 Barrels Grease to St(ation)’. This was


In 1986, the Annual General Meeting was held at Cowick Hall, where a very special guest was Mr J Stones from the nearby village of Stillingfleet. It was his father who transported by horse and cart the very first three barrels of lanolin to be made at Rawcliffe Bridge in 1925 – Croda’s first year of operation.
In fact, as a centrepiece for the accompanying exhibition at the AGM, Mr Stones kindly arranged transport to Cowick Hall of the very same cart that was used back then. Today, the cart has a permanent resting place at Mr Stones’ farm. Mr Stones was a young lad at the time but he remembered A P Wood as a ‘big chap – we were always pleased to see him at the works as he could load two kegs at a time, so we could be on our way to the station much quicker!’



1930
Report from National Physical Laboratory shows that lanolin is an effective rust preventive, leading to the development of Croda Fluid to meet the NPL specification.
1931
Croda’s first profitable year.
1932
Edgar Lower, later to become Croda’s first Technical Director, joins the company as a 14-yearold to help out in the laboratory.
1933
Development of range of lanolin bases for use in cosmetic manufacture, including Cremba and Isocreme.
1935
Lanolin successfully split into lanolin fatty alcohols and fatty acids, resulting in the creation of Hartolan (‘the Heart of Lanolin’), a superior emulsifying agent for cosmetic creams and lotions.
1937
London office established.
1939
Outbreak of war leads to close collaboration with the Government to produce a variety of wartime speciality products.

As the 1920s drew to a close, the National Physical Laboratory published a report on the effectiveness of lanolin compared with existing types of rust preventives. This showed lanolin to be far more effective than the other products in use. With this authoritative backing, it was decided to proceed immediately with the manufacture of a rust preventive to the specification outlined by the National Physical Laboratory – and so, ‘Croda Fluid’ was born. The product recommended was a 30% solution of lanolin in white spirits. The method of manufacture was simple to say the least. The lanolin was melted in an empty 40 gallon steel drum standing on a few bricks over an open fire. When it was melted, the fire was put out and white spirits quickly poured in and mixed.
Working alongside government departments and leading engineers, what was initially a single grade was expanded to create a range of products for different engineering applications, including car plants and assemblers of consumer durables. These applications were soon to diversify further. With the darkening clouds of war, more and more manufacturers turned to armament production, where freedom from rust was essential. The early ‘30s saw a turning of the tide, and 1931 was a profitable year.

Although Eric Cannon had originally joined the company as Secretary, like A P Wood, he ‘wore a number of different hats’. When not out selling, his principal role, he worked in what was euphemistically called ‘the laboratory’, which was actually the kitchen of the house on the site in which Wood had lived.
Whilst working in the laboratory, Cannon was joined in 1932 by a 14-year-old local lad who had instructions to wash the pots and the floor, and make himself generally useful. This boy, Edgar Lower, displayed an almost fanatical determination to master every aspect of lanolin and associated products, eventually becoming a world authority on the subject. He joined the Croda Board in 1946 as Croda’s first Technical Director, retiring from that role in 1974. But that was a long way in the future from the mid 1930s, when he gradually took over the laboratory from Cannon and became Chief Chemist.
Much of Croda’s early product range was devised in this period by Edgar Lower. Because lanolin also possessed emollient or ‘skin softening’ properties, it was a natural choice, literally, for cosmetic preparations. Lower became increasingly interested in this field and began to develop a range of lanolin bases for cosmetic manufacture.

In 1934, Edgar Lower and Eric Cannon started experiments to chemically separate lanolin into its two major components: lanolin alcohols and lanolin fatty acids. This was already being done in Germany and it was known that the alcoholic fraction was a superior emulsifying agent for cosmetic creams and lotions. Despite the somewhat crude laboratory facilities and their own relative alcoholic fraction, which A P Wood named Hartolan (i.e. containing

the ‘Heart of Lanolin’). The subsequent development of a product that was soon to become known around the world showed an early sense of ingenuity and creativity – traits that were to characterise Croda’s future progress.
As an example of this, the plant needed to manufacture Hartolan in bulk was elaborate and expensive at a time when Croda had very little money. At the same time, A P Wood became aware that a large and prosperous Bradford wool mill, W & J Whitehead Ltd, was planning to enter the lanolin business. To counter this, Wood proposed to Whitehead’s that instead of making lanolin, and thereby creating unnecessary competition, they should manufacture this remarkable new product, Hartolan, which in turn, Croda would market. Perhaps surprisingly, Whitehead’s actually liked this idea, resulting in a fruitful and long-term partnership between the two companies. The whole episode was an example of Wood’s early preference to concentrate on sales and marketing. However, as Croda embarked on its quest to achieve the highest standards of quality and performance in an increasing regulatory world, the benefits of a strong manufacturing base and a skilled, dedicated workforce, would become increasingly apparent.

As the decade progressed, thanks to steady sales of lanolin and its new derivatives, Croda managed to increase profits slowly and stay afloat. There were frequent slack periods, however, when manufacturing had to be stopped and men had to be laid off, affecting morale. Diversification was tried. A new company called Charlotte Toilet Lanolin Company was formed to pack lanolin into small tubes and pots for the retail market. This was not successful, however, serving to hammer home the message that there was a world of difference between industrial selling and retail marketing. The moral of the story: the cobbler should stick to his last – stick to what you know and what you do best (advice that would prove to be almost prophetic at times during Croda’s centenary journey).
An indication of the austerity of the times is that it was common practice for the bosses to pass down their clothes to the workers. The workforce was not much bigger than a large family and indeed, there was a strong family ethos, exemplified by annual one-day trips to the seaside.
Eventually, however, the relentless quest for new markets began to bear fruit. The general economy started to improve and with it, Croda’s fortunes. By 1938, the number of men employed in the works had crept into double figures. Wages at that time were one shilling per hour. Eric Cannon was spending more and more time out selling, particularly in the south of England, so it was decided to set up a London office where he would be based.
Cannon also travelled regularly to Europe where Croda was starting to establish new and important markets. But then, just as fortunes had changed at the beginning of the decade, the dawn of a new one was to bring further massive change with the outbreak of war.
Edgar Lower’s focus shifted rapidly to studying Government specifications, selecting those products that Croda could supply. Fortunately, the existing plant, although quite basic, was ideally suited for blending operations, and the know-how Croda had quickly acquired whilst working closely with the Government’s own technical staff was to prove invaluable in shaping the next chapter of the Croda story.


By Edgar Lower
My first day at Croda will never be forgotten – I was terrified! I was 14 and had left school during the Christmas holiday. My role in the organisation, between joining in 1932 through to 1936, was manifold.
I washed the office floor, opened all the mail with one of our typists (Miss Setterington) and, in my role as Assistant Chemist, made up samples and helped out in the works whenever and wherever I could.
Here my duties included firing up the boiler, cleaning the grease traps out, along with the dyke that ran through the site, helping with a little extemporary pipe fitting, stencilling barrels of lanolin and stamping the post. At that time, Mr Wood (senior) was very keen on sending out samples of ‘White Swan Lanolin’ with every circular letter, so apart from preparing hundreds of samples, I also helped to insert them in the envelopes and transport them to the post room in my special ‘carrier’… a waste paper basket. I seriously consider that sending out samples in this way helped to establish Croda Limited.
“

Edgar Lower joined the technical staff in 1932, rising to the position of Chief Chemist.
He was elected to the Board in 1946 as Croda’s first Technical Director.

1946
Edgar Lower becomes Croda’s first Technical Director.
New generation of lanolin derivatives and surface active agents developed, including Isocreme, Cremba and Polawax, which is still widely used today in cosmetic preparations.
Industrial and decorative paints developed to replace camouflage paints used during war.
Headquarters move to a former vicarage in Snaith, re-named Croda House.
1949
A P Wood dies at the early age of 46. George Crowe and the Board opt for committee style management, with Fred Wood appointed Sales Director at the age of 23.
The factory worked day and night to meet Government demand for various wartime products
When the Second World War broke out, with the threat of wide-scale bombing, the Government decided to camouflage aerodromes, army camps, power stations and industrial premises.
As a result, one of Croda’s first contracts was to supply huge supplies of camouflage paint, requiring the installation of paint manufacturing equipment, which would in the future become a valuable asset in meeting post war shortages.
Edgar Lower made a study of the whole range of Government specifications to ascertain which products Croda could make.
The demand for Government specification rust preventives rose sharply with the armament drive, made for every theatre of operations, from the Arctic to the Burma jungle.

Vast quantities of dubbin protective (a waxy product to soften and waterproof leather) were required by all branches of the Armed Forces – more than three million tins were despatched to all parts of the world. Camouflage face creams were produced for commando operations. Over two million tins of foot soap left the Croda works, along with gun cleaning oil and soldering solutions, de-icing fluids for aircraft and barrage balloons, and anti-gas oil.
As the war moved towards the east, new foes were encountered – the insects and mites which initially took a huge toll on both men and materials. It quickly became clear that every soldier must be given some means of personal protection, which resulted in Croda handling another new product: insect repellent. Ever increasing quantities were required and by the end of the war, Croda had supplied the enormous total of over six million tins and bottles.
As time went on, almost all of the men at the site were called up for the Military and by the end of the war, much of the actual process and manual work, and all of the office work was carried out by women.



When the war finished and the men came home, Croda was a very different company to the one they had left six years earlier. The company had invested heavily in the new plant that was needed for the expanded product range, but profits had been capped by Excess Profits Tax Legislation, so whilst of a reasonable physical size, Croda was grossly under-capitalised. This did not bode well for the difficult years ahead as many of the newly developed wartime markets largely disappeared.
Nevertheless, for a time, all was well. Sales were booming to the extent that a new home was required for the sales office, which was no longer fit for purpose and still embedded in the middle of the Rawcliffe Bridge site. Without the funds to build a new office, the company looked around for an existing building. As it happened there was a large, old Georgian vicarage in the town of Snaith, where Wood was now living, some five miles from the Rawcliffe Bridge site. Negotiations with the church authorities took place and the vicarage was bought and transformed into what became the company headquarters from 1946 to 1955.
A new pilot plant and a paint research laboratory were opened, developing a full range of industrial and decorative finishes replacing crude camouflage paints, with a ready-made market for a public starved of consumer goods.



Following on from the research work carried out by Edgar Lower to develop new lanolin-based derivatives, such as Hartolan, Cremba and Isocreme, another post-war development was the introduction on a commercial scale of surface active agents, not just for cosmetic applications, but across industry generally, acting as emulsifiers, detergents, wetting agents and solubilisers. Innovative new surface active agents were sold under the names of Crill, Crillet and Cithrol, some of which were so effective they are still used in cosmetic preparations today. (There are several twists of fate in the Croda story. Crills and Crillets were the Croda counterparts of the industry leaders, Spans and Tweens – products that would in turn become part of Croda’s portfolio when Uniqema was acquired some 60 years later).


Despite this wealth of new products and what was initially a sort of commercial honeymoon, trading became increasingly difficult, and the late 1940s were mainly concerned with returning to peace time normality. The war had been beneficial in terms of business expansion but much of this was of a largely profitless nature. In fact, the last quarter of 1948 saw the company actually trading at a loss for the first time in over a decade.
The Board, which had remained unchanged since 1928, was now augmented by Norman Duckels, the pre-war Secretary, who on his return from war service, took over Production. His younger brother, Leslie, joined the company as Secretary. Edgar Lower was the Technical Director. The new Board was faced with a dilemma. Should they deliberately cut back Croda to something like its pre-war size or should they go forward, armed with their growing product portfolio? Leslie Duckels prepared a document: ‘The diagnosis and the remedy’, suggesting that they aim for a profit of £1,500 per month using Croda’s tried and tested traditional method of increasing sales.
The disappointing management accounts were the last ones A P Wood was to see. In March 1949, he made a hurried trip to New York to draw together the old pre-war lanolin business. On his return, he went into hospital for what should have been a straightforward operation, but sadly died of complications the following day at the early age of 46.
To Croda’s management, the loss of their leader seemed an overwhelming catastrophe. Wood hadn’t had time to delegate much of his work, and the crucial decision regarding whether to expand or contract in line with Leslie Duckels’ recommendations, had still to be taken. Things looked bleak as the first 25 years of Croda’s history drew to a close.
By Kurt Neulinger

Does anyone still recall the offices at the Old Vicarage – ‘Croda House’ - in Snaith back in 1948? ‘APW’ and his son, ‘FASW’ (Philip and Frederick Wood) presided in the Boardroom, which also served as their office, across the street from the church and cemetery – laughingly called the ‘retirement arrangement’. Norman and Leslie Duckels led the administrative functions, and lunched at a separate table in the downstairs canteen. Phil Thompson and Walter Shand (Purchasing) and later Eric Miller (Paints) and myself ate at a small table for four. The Export department, which I joined as a refugee from communism in Czechoslovakia, consisted of Miss Walters and George Rochester (Shipping). Edgar Lower at Rawcliffe Bridge was the pioneer of woolgrease and lanolin technology.
I will never forget the camaraderie and gracious welcome all of them extended to me and my wife, Bozena (Bobby) as we adjusted to our new life of freedom. Apologies to anyone whose name I omitted, but all these great people were the nucleus from which the current, magnificent, worldwide Croda company originated.

before transferring to the US where he became VP
1950
Croda celebrates its 25th anniversary. Fred Wood sets up sales office in New York.
1953
Fred Wood returns to the UK to become Managing Director. He is succeeded in the US by Mike Cannon, the son of Eric Cannon, A P Wood’s colleague of 25 years earlier.
Croda’s first major merger with C M Keyworth of Leek, a supplier of fatty acid esters to Croda.
1954
Founder and Chairman George Crowe dies and is succeeded as Chairman by his brother, Sir Edward Crowe, a former diplomat.
1955
Croda acquires the lease to Cowick Hall, a beautiful but neglected noble mansion which, after renovation, becomes the group headquarters.
Lanolin manufacturing operation established in Italy, Croda Italiana, headed by Harry Rosson from the UK.
1957
Croda Inc, USA purchases the lanolin business of Hummel Chemical Company, renaming it Hummel Lanolin Corporation. Production is transferred to a newly constructed plant at Newark, NJ.
1959
Sales operation, Croda GmbH, established in Germany, headed by Maurice Thwaite, a former sales representative in the Midlands.
Brochure and covering letter to celebrate




As Croda entered the new era of the 1950s, the original team that had started the company twenty five years earlier had virtually gone. A P Wood had recently died and Dawe had left the scene many years earlier. George Crowe had left the running of the business for the first 25 years to his nephew, but he remained as Chairman. Now, aged 80 and in poor health, he found himself without a successor to A P Wood, so decided to try and draw the management team together. In the absence of an obvious leader, Crowe and the Board settled for committee management without designating a Chief Executive – a management structure that was to last for the next three years.
The new Board agreed that they must press ahead, even without the man whose name had been synonymous for many with the company itself. Recovery was slow, but by April 1950 it was sufficiently advanced for a celebration to be held in the Co-operative Ballroom in Doncaster, attended by some 125 employees out of a total workforce of 130. A brochure celebrating the first twenty-five years was produced concentrating wholly on growth. Croda was still small in size but it had survived the crisis and looked forward with optimism: optimism that turned out to be well founded.

The pattern of trading initially returned to the basic model focusing on lanolin and derivatives, mainly developing in two directions. The first was as a supplier of speciality raw materials for other manufacturers’ products, such as lanolin in cosmetics. However, this was soon to diversify, leading Croda to develop an evergrowing product portfolio for a wide range of markets. Cosmetic applications led to pharmaceutical and veterinary applications, and then into other areas such as household products.



The other principal stream was the manufacture of simple industrial products, often blends based on lanolin and other oleochemicals. This had already been done before the war with simple rust preventives, but in time these became more sophisticated, developing into industrial paints and lacquers, specialised lubricants and steel rolling oils, and a new generation of rust preventives. An interesting development in rust preventives was the introduction of plastic type anti-corrosives. There were two types of material, one a ‘hot dip’ product called Crocell, that left the metal part sealed with a tough, thermoplastic skin, which exuded a fine oil on the metal during storage. The other was a ‘cold type’ product marketed as Lowerite (named after Edgar Lower) which resulted in a much thinner skin. Both types could be easily removed by slitting open the skin, so the plastic film could be peeled off.
The driving force was the marketing system employed by Croda. Initially, under A P Wood, it had focused almost exclusively on direct mail, but increasingly it relied on market intelligence supplied by a team of ambitious local sales representatives, whose aim was to forge strong relationships with customers – a strategy that still applies today. Their role was to determine just what the customer needed and then the laboratory would try to come up with the right product. This emphasis on close customer relationships and problem solving often resulted in unique, tailor-made products, that not only satisfied the customer but made the business more secure. In effect, Croda had become a market-focused company - before anyone at the company really knew what that meant.
For its size, Croda had built a reasonably large sales force of high calibre, many of whom were young men who had returned from the war, keen to make headway in a post-conflict world. This resulted in a steady, but strong increase in sales, reflected in the fact that many of those representatives went on to take senior management positions within the company.


Overseas sales were beginning to expand, mainly via a welldeveloped and extensive network of agents and representatives in many countries. The directors were well aware of the potential of the North American market, where most of the world’s leading cosmetic manufacturers were based. In 1950, Croda made contact with an American wool magnate, Arthur O Wellman, who wanted to make lanolin in that country from his by-product, woolgrease. Wellman agreed to a joint venture on a novel basis. Croda would develop its activities in the US through the venture and, in return, Wellman would provide office space and salary for one man for one year. That man was Fred Wood, the son of A P Wood, who, at the age of just 23, had recently been appointed as Sales Director. The move to America with his wife and baby daughter seemed a good way for Wood to prove his worth.
The US venture was very much a marketing effort and by the end of 1951, a reasonable profit had been made. Fred Wood hired a secretary and then a salesman, who was destined to figure prominently in the history of Croda in America. His name was Kurt Neulinger, and he had joined Croda in the UK as a sales manager, but decided early in 1952 to try his hand in the US, later becoming VP and Director of Marketing for the US companies.
The sales office in New York initially offered the Croda range from UK supplies, but gradually developed a product range made in the US on a contract or toll basis. To say the existing US lanolin manufacturing companies were not too worried about Croda’s entry into the market was an understatement. Jack Butscher, who was to become VP of Croda Inc, was at the time working for Hummel Lanolin Corporation, a long established producer – who were eventually acquired by Croda. While attending a meeting of American lanolin producers in the early 1950s and enquiring why Croda was not represented, a senior executive of one of the companies present replied: “They only have a collection of tin huts that they call a plant, they’ve never made any lanolin, and they’re only nuisance value.”
However, ‘the nuisance’ was in fact doing very well and by 1953, four separate manufacturers were supplying Croda with its required products. The increasingly successful marketing effort was spearheaded by a prolific industrial direct mail campaign whilst forging close relationships with customers, in very much the same way as the parent company had done a quarter of a century earlier under A P Wood.
Buoyed by Fred Wood’s success in the US, by mid 1953 it was agreed that he would return to the UK to take over as Managing Director. In another of those twists of fate, he was succeeded in the US by Mike Cannon, who had been training in the UK for a number of years and was the son of Eric Cannon, Wood’s father’s partner of 25 years earlier. The successful US operation demonstrated a good example of two Croda characteristics: providing ingenious solutions to customers’ problems, and exploiting the marketing strength of the management.
Back in the UK, business had settled down on a rather dull plateau. Sales were split between those products made at the company’s only factory at Rawcliffe Bridge, and those made on its behalf by other manufacturers, including lanolin alcohols (Whiteheads), fatty acids (Universal Oil Company), castor oil (Premier Oils) and fatty esters made by C M Keyworth & Company of Leek in Staffordshire – the latter becoming an increasingly important supplier of products to Croda.
C M Keyworth was strong on technology but weak on marketing, so the two companies complemented each other. In 1953, the owner, Maurice Keyworth, decided to sell his company. Following a hurried Board meeting, Croda made a successful bid. Fred Wood noted that this first major merger illustrated the significant benefits that can arise from a combination of strategic mergers or acquisitions with organic growth.

Croda advertising in the mid 1950s
They only have a collection of tin huts that they call a plant. “ “

As mentioned in the narrative, from its earliest days, a highlight in the social calendar was the annual Croda trip. Mary Bruines, formerly of Cowick Hall (1950 to 1989), recalls: “No-one will forget those wonderful trips to Blackpool, Scarborough and London, with the men carrying crates of beer and bacon sandwiches on board our own private, early morning train.
A favourite of mine was the Festival of Britain outing to London’s South Bank on 26 May 1951. Note that the train left Goole station at six in the morning and didn’t arrive back in Goole until quarter to five the following morning, almost 24 hours later.”
John Chester (Croda Chemicals, 1956 to 1994) recalls another Croda trip to the Lake District, during which the company had organised a boat trip on Lake Windermere. “Most of us arrived at the jetty early and settled down to wait for the boat. It was a very hot day and Bert Taylor, the then Rawcliffe Bridge Works Manager, sat on a bollard, took off his flat cap and dropped it in between his feet whilst he mopped his brow.
“By this time, the jetty was becoming quite crowded as people were arriving to board their various boats. One of the lads from the works, walking past Bert, threw a few coppers in his hat for a joke. This started the ball rolling, and as other passengers walked past, many others similarly tossed coins into Bert’s hat. Bert, renowned for his dry sense of humour, kept a straight face and held his ground – or should I say his seat on the bollard. He was eventually coaxed off and boarded the boat, where he – and the rest of the Croda gang – collapsed into fits of laughter. When we had all recovered, we counted the money Bert had ‘collected’ and found it to be a not inconsiderable sum. The somewhat ill-gotten gains were spent on drinks aboard the boat and, thanks to the generosity of the Great British public, a very merry time was had by all!”




Croda House, the former vicarage in Snaith, had served the company well as its headquarters since 1946, but the steady growth of the business and the workforce brought with it accommodation problems. Fred Wood was on the lookout for something more suitable. The answer to his, and Croda’s requirements, was actually located a few miles away from Snaith, just off the main road to Goole, and also close to the company’s main factory at Rawcliffe Bridge: Cowick Hall, the former country seat of Viscount Downe. Once the home of aristocrats, tycoons and farmers, this still noblelooking building with its rich façade, one of the finest late 17th century houses in the land, was in a sorry state and the subject of a demolition order.

Though mainly interested in its potential as a new headquarters, Fred Wood admired the architectural distinction of the Hall and felt that it would make an appropriate visual statement of the Croda organisation. Accordingly, in 1955, a lease of the Hall was obtained from the then owners accompanied by a grant towards the external repairs by the Ministry of Works. The terms of the agreement gave the company the option to purchase within the ten-year period of the lease and, in 1963, that option was exercised. Croda bought the Hall and the surrounding 73 acres of land, giving a new extension of life to Cowick Hall, which has remained as the group’s headquarters ever since.
A further overseas base was established in 1955 when Croda started a lanolin manufacturing operation near Milan in Italy, in partnership with Marzotto, a large Italian textile company. Croda’s manager was a young Englishman, Harry Rosson, who, with his wife, Wilma, built up the business. As in the US, however, it was soon found to be better to go it alone, and production was moved to a new site outside the village of Mortara.
With lanolin sales increasing in the US, in 1957 Croda Inc purchased the lanolin business of Hummel Chemical Company, renaming it Hummel Lanolin Corporation, and transferring production to a newly constructed plant at Newark, NJ.
In 1959, Croda started a sales operation, Croda GmbH, in Germany near Düsseldorf. The venture was initially staffed by just one man, Maurice Thwaite, a former sales representative in the Midlands, who gradually built up a strong sales team. Back in the UK, Fred Wood, who by then was firmly at the helm, was able to push forward his ideas, including a sweeping reorganisation of the sales team, rapidly promoting some of the company’s younger men.
George Crowe had died in 1954 and was succeeded as Chairman by his brother, Sir Edward Crowe, a former diplomat. Following Sir Edward’s death in 1960, Fred Wood became Chairman as well as Managing Director. The cumulative effect of these changes on profits was almost immediate, heralding the dawn of a new decade.



By Sir Frederick Wood Former Chairman and CEO, Croda International
In October 1950, I found myself in New York with a briefcase, a small desk and a mandate to start up a Croda subsidiary in America – but no capital. Back home in England, Croda had survived a crisis and was a sturdy growing enterprise, so I felt justified in printing an introductory advertisement in a leading US technical journal which said: ‘Croda – the fastest growing name in fatty chemicals.’
This was, of course, whistling in the dark. It was the child sticking his chest out in the world of giants – but in fact the child grew faster during the ensuing 25 years than any of its competitors and thus justified that outrageous statement.


1960
Sir Edward Crowe dies. Fred Wood becomes Chairman as well as Managing Director.
1964
Croda becomes a public company. Croda Nippon formed in Japan as a joint venture with Sansho Oil & Fat Trading Co.
1965
Croda Inc purchases site at Mill Hall, PA, to expand manufacturing facilities in the US.
1967
Croda buys United Premier Oil Company, a long established company involved with oil seed crushing and refining.
1968
Croda buys British Glues & Chemicals, a major producer of gelatin and tallow, an important raw material for the manufacture of fatty acids.
Croda Canada formed in Toronto by John Brown, formerly of BGC.
Croda buys Bowmans Chemicals of Widnes, a manufacturer of food acids and specialised chemicals for metal finishing.
Croda buys three small companies in Australia to form Croda Federal Chemicals headed by George Hembrough, who previously ran Croda’s Leek factory.
Cowick Hall Aviation formed to transport executives throughout the UK and Europe.

In 1960, annual profits had leapt to £134,000 and in the next three years grew dramatically so that by June 1964, Croda could go public. The shares were duly offered for tender by L Messel & Co. Press comment was reasonably favourable, but not overenthusiastic, although one notable and influential exception was John Davies of the Observer, and before that the Financial Times. Over the years, he had developed strong views about the ingredients of a successful company, many of which he saw in Croda, in particular having the right sort of leader in Fred Wood. Although Fred Wood now had the means to buy companies, he decided to set up Croda in Japan as a joint venture with Sansho Oil Fat and Trading Company, a company specialising in lanolin derivatives and with whom Croda had a close relationship stretching back many years. This joint venture, Croda Nippon, unlike some before it, was to become very successful. Meanwhile, in North America, Croda Inc purchased a site at Mill Hall, PA, to expand manufacturing facilities in the US.
By 1966, Croda was establishing a strong reputation in the chemicals field. The company’s rating was good and the market view of the management was so favourable that a takeover or merger of significant size became a distinct possibility. A provisional list of possible targets was compiled, although many of the names seemed to be too large and well known to be persuaded to join Croda.
The first name on that list was Hull-based United Premier Oil & Cake Company (UPOC), whose main activity was crushing and refining oil seeds and nuts, such as castor, soya bean, groundnut and rapeseed. One of the companies in the group was Universal Oil Company, which manufactured fatty acids, vital building blocks of the oleochemicals industry and sold to a wide range of industries. After the acquisition of C M Keyworth in 1953, fatty acids became an important raw material for Croda as they were needed to manufacture fatty esters. A link up with Universal Oil Company seemed logical, but a tentative approach to the company was quickly rebuffed.
Instead, Croda began to look again at the whole UPOC group of companies and by the summer of 1967, was ready to make a bid, riding on the back of the fact that its reputation as a small but dynamic and growing company was high in Stock Exchange circles, whereas UPOC had just returned its lowest profit for some years. Despite the disparity in size, Fred Wood thought that a merger might be possible and an offer was duly made. Despite strong resistance from the UPOC Board, with further offers and rejections, a deal between the two companies was eventually sealed on 30 June 1967.


By Mary Bruines Croda International, 1950-1989
How often, when we meet ex-colleagues, after first asking if they are keeping well, the next question is usually ‘Do you remember when…?’ Well – I remember when:
I started at Croda House in Snaith in August 1950 at a salary of one pound ten shillings per week (£1.50). The first person I saw was Peggy Claxton at the complicated ‘plug-in’ switchboard that we all had to learn how to use. We had a hand-operated franking machine and every night a junior had to carry the mail bag to the Post Office.
Croda Way magazine started off as ‘Concorde’ and we all used to write articles. A group of us wrote one including bits about The Beatles and Cliff Richard. In 1956 we moved to Cowick Hall – files and furniture first, then personnel on the Croda bus, with typewriters on our knees.
Walt Bentley, the gardener/handyman (his wife, Mrs Bentley, ran the canteen) drove off from Cowick Hall with the bank bag on top of the van – panic stations… We went out with a search party and found it just outside the gates on a grass verge! And, of course, there was Walt’s dog, Sandy – a favourite at Cowick.
Croda trips – no-one will forget those wonderful trips to the seaside and sometimes London – and the Croda dances at the Baths Hall in Goole and Co-op Ballroom in Doncaster, when the Twist was in its heyday!
I lived at ‘The Lodge’ in the grounds of Cowick Hall – my little ‘Shangri-La’. So many happy, happy times and precious memories – nothing to replace them…


Further plans begin to gel
In the early days after the merger, Fred Wood visited the Universal fatty acids plant at Hull with Cecil Manson, a former UPOC Board member who had been appointed as a Managing Director at Croda. As they walked around the yard, they noticed a drum of tallow, a major raw material in the manufacture of fatty acids, marked ‘British Glues & Chemicals’, prompting a discussion of this company as a possible future acquisition.
British Glues & Chemicals (BGC) had in fact been on Croda’s radar for some time as a possible takeover target, mainly due to its position as one of the two major UK producers of gelatin. Gelatin was used extensively in photographic film, foods and pharmaceuticals - the type of product that fitted well with Croda’s fast growing portfolio. BGC was also strong in animal glues and synthetic adhesives, including the well-known ‘Croid’ brand for hobbyists.


Most important, however, there was also the production of some 18,000 tons of tallow – more than enough to hedge Universal’s needs for fatty acid production. With a dozen or so factories around the UK, and bone processing works in Austria and Holland, BGC was larger in assets, turnover and employees than Croda, even after the UPOC merger. However, the disparity in size held no fear for Croda. Whilst strong technically, BGC noticeably lacked flair and imagination – key Croda attributes.
In July 1968, an offer was made by Croda which was speedily rejected by the BGC Board. A series of increased offers were made, all of which were similarly rejected. The whole process became increasingly acrimonious, and was widely reported by the business press, who were themselves beginning to take sides. On 14 September 1968, an increased offer was finally accepted, ending a long and bitter ‘David and Goliath’ type confrontation in which, once again, Croda, cast firmly in the role of ‘David’, had prevailed.
When the battle was over, the respective Croda and BGC Board members sat down to share their views on the future. Despite the strenuous opposition to the Croda bids, there were no recriminations – indeed, as with the UPOC merger, many of the BGC personnel were keen to avail themselves of the opportunities that arose within the expanded Croda organisation. John Brown went on to establish a sales office in Canada. Another former employee, George Bates, went on to become Secretary at Croda, also joining the Main Board, along with several other senior BGC personnel.
A key commentator of the time, Mike Hyde, who was editor of the influential Chemical Age magazine, stated: “The ability of Croda I most admire is that of seeking out the hidden talent in acquired companies on which the future could be built.”

Press cuttings at the time of the Croda bid for BGC
By Jack Thewlis Croda Chemicals, 1964 to 1998

It was just as I’d seen it before: ‘The Croda’. That’s what people called it when I was a kid. The last time I saw this incongruous collection of industry, plonked in the middle of a sleepy little village, I was barely into my teens.
I had no idea what they did. What mysteries all of those tin sheds and hundreds of drums contained. And the chimney – the tallest thing for miles. And the black stuff, ash-like and crunchy under foot. It was everywhere – down the slope to the gates by the canal. And there were bikes. There were bike sheds everywhere. But what do they do here? “Paint,” said the old chap nearby. “They make paint.” So now I knew. Looking around at the drums and sheds and the name written large, I reckoned he was right. It was green paint, for sure.
So here I was again. It was 1964. I was 21, straight out of university and rarin’ to go. As I ventured down the slope, I was a little concerned about the effect that the black stuff might have on my shiny new ‘winkle-picker’ shoes and the bad impression it might create.
On arriving at the offices, I realised it didn’t matter. The trails of the black stuff went everywhere; from the bike sheds, into the offices and straight to the boss’s door. The boss, who was known as ‘ND’ (Norman Duckels), sat behind an enormous wooden desk. He looked the part. I was nervous, but confident. Having just graduated in chemistry, I thought I knew it all.
Following his welcome and a brief description about what went on at Rawcliffe Bridge, he threw me a few questions about fats and fatty acids. This is easy, I thought. Then, sitting forward in his chair, ND was clearly about to deliver the key question. It was make or break time. “What do you know about Molecular Distillation?” Whaaat… I screamed to myself. But I swallowed, looked him straight in the eye and replied, “Oh, a little.” “Good,” he said. “Can you start next week? You’ll be running a molecular still, it produces Stutz.” It turned out that Stutz was the code name for Super Hartolan. There were lots of names like that, names of American cars. The Big Boss (Fred Wood) loved American cars and drove one around the town. So that’s where I started learning about Super Hartolan. It eventually took me 34 years to ‘know it all’.



Before the dust had settled, Croda made a successful bid for another company on its list of possible targets: Bowmans Chemicals of Widnes, who manufactured important food acids such as lactic acid and malic acid, as well as speciality chemicals for metal finishing. By late 1968, Croda had not only acquired the mighty BGC, but also the not inconsiderable Bowmans Chemicals. Meanwhile, an important move was made overseas in Australia. Throughout the early 1960s, Croda had been considering the possibility of manufacturing lanolin there because of the large local production of woolgrease. Following a visit to Australia in early 1968 by fellow directors Don Jackson and George Hembrough, they managed to seal a deal to purchase Lanoline Products Limited, a small but successful manufacturer of high quality lanolin, along with two family run chemical businesses, E I Noble & Co Ltd and Federal Holdings Ltd. In just three short months, Croda had laid the foundations to becoming a significant player in the Australian chemical industry.
After the explosive growth during 1967 and 1968, it was time to concentrate on reorganising the management structure both at home and abroad in order to absorb the new businesses. All trading activities were split into five major divisions: Chemicals (the original activities at Rawcliffe Bridge and Leek, plus the Universal fatty acid plant at Hull); Food Products (the gelatin activities of BGC plus the acidulants that had been part of Bowmans Chemicals); Polymers (the former glue manufacturing plants of BGC and former Paints operation at Luton); Agricultural (the collection and processing of bones before they were turned into gelatin or glue); and finally, Premier (the edible oil activities of the former UPOC group).
In addition, there were one or two small operations that did not fit into any of the above divisions, a notable one being Standard Soap Co Ltd, formerly part of BGC. A bold decision was made to dispense with the company’s existing trade to focus entirely on private label operations, making soap and toiletry products such as the popular ‘Soap on a rope’ for some of the leading cosmetic houses. As a result, Standard Soap was to become one of the fastest growing operations in the Croda organisation.
The group now had quite a wide spread geographically, both in the UK and Europe, with its executives faced with an increasing amount of travel. Several of the team had service in the RAF or Fleet Air Arm during the war, so the company was ‘aviation minded’. It was no surprise, therefore, that Fred Wood decided to buy his own light aircraft in the early 1960s and learnt to fly. The idea of having a company aircraft and professional pilot became increasingly attractive and in 1968, Croda purchased a twin-engined Cessna 336, engaging the services of a recently retired RAF Squadron Leader, Bill (Captain) Olsen, as the company pilot. Cowick Hall Aviation, as it was called, was soon expanded to two planes and two pilots.
Whilst this breathing space with a period of consolidation had been much needed, after the heady and exciting days of the swinging sixties, Fred Wood and the Board were never going to rest on their laurels. Once again the time was ripe for further growth.


Any colour you like – as long as it’s black… and green, yellow, blue and red.
Within a short space of time, Croda had changed from being a relatively small to a medium sized company. In turn, it had to start thinking about itself in different terms and the ‘image’ it portrayed. Croda’s corporate identity had always been important. Even from the early days of A P Wood, much attention had been paid to items such as stationery and packaging, and this passion for good design was obviously a family trait, inherited by Fred Wood. Inevitably, with new companies joining the organisation, the overall image had become fragmented, so it was decided to create a definite and tightly controlled ‘house style’ that would be applied to every aspect of Croda’s image.
The company retained a Manchester-based design consultant, Norman Wilson, to oversee the project, creating a new identity that would reflect a dynamic, modern thinking and by now, much larger organisation. A design manual showing detailed guidelines was created and the company even set up its own in-house printing department at Cowick Hall to oversee the implementation of the new image, which has continued to evolve over the years under Croda’s design consultant, Anthony Dawson, who was Norman Wilson’s associate way back in the 1960s.
For several years in the 1980s, the corporate identity reflected the group’s organisation. Each of the four principal subsidiaries had its own corporate colour: Chemicals (green), World Traders (yellow), Organic Chemicals (blue) and Polymers (red). Each colour was applied to all aspects of their respective corporate identities – from stationery to signing, even extending it to sartorial applications, such as ties and headscarves, proudly worn at exhibitions and corporate functions. Visually, it was colourful and good fun, even invoking a sense of competition (the ‘Reds’ were particularly proud of their vibrant variant).
But it was far more than just visual. Each of the principal subsidiaries had its own central management. No longer just one company, Croda had evolved into four competing operations. The corporate identity had become diluted, but of far greater concern, Croda itself had become fragmented. The principal subsidiaries were soon dismantled and, with the formation of an Executive Committee, Croda once again became a single company with a unified purpose.
Croda launched its new branding as part of its centenary celebrations early in 2025. “ “



By Captain Bill Olsen, Company Pilot, Croda International 1968-78

During the ten years that I was associated with our aviation operation, we flew in fair weather and foul, much of it in and out of our Cowick Hall airfield. For several months of the year, return to Cowick Hall after a day’s work meant having to land in the dark on a nottoo-long, grass runway. At the larger airfields, this was no problem, with approach and runway edge lighting. However, the expense of full electric runway lighting for our small operation could not be justified, so we got round it using Croda’s well established approach to innovation and problem solving…
We bought a couple of dozen car front number plates and attached them to wooden stakes at prescribed distances along the edge of the runway. When the aircraft was at about half a mile or so on its landing approach, the aircraft landing lights would be switched on by Stuart Tasker and his trusty Cowick Hall site maintenance team… and, hey presto… the highly reflective runway lighting sprang into view.
During my time with the flight department, we travelled many thousands of miles during the five thousand or so flights, landing at over a hundred aerodromes and airstrips throughout Western Europe – and happily, we didn’t bruise any passengers along the way!

Croda buys L&H Holdings, which makes processed vegetable oils at Hull and Barking.
Croda buys A B Fleming, which makes printing inks, graphic supplies and synthetic resins, also giving it a foothold to form Croda South Africa.
Croda buys London Oil Medina, a leading distributor of edible oils for the food and bakery industries.
Whilst remaining as Chairman, Fred Wood hands over his Chief Executive responsibilities to Ernest Tyerman, formerly head of the Polymers division.
Formation of Croda France, Croda Brazil and Croda Japan.
Croda acquires Midland Yorkshire Holdings, which makes synthetic chemicals, road tars and bitumens.
Croda buys Kenneth Thelwall & Co of Doncaster, a long established manufacturer of blended oils and greases for the mining and automotive industries.
In Australia, Croda acquires the Lusteroid group of companies, which makes printing inks and paints.
Croda Japan develops Super Refining technology to create ‘Snow White Lanolin’. Croda celebrates its 50th anniversary.
1976
Croda launches Crotein Q, the first in a long line of market-changing protein derivatives for hair care.
Chairman Fred Wood receives knighthood. Croda buys Kimpton Brothers, traders in spices, waxes and gums, which also includes Manley Ratcliffe, the UK’s second largest honey producer.
Croda buys Thornley & Knight, which makes vehicle paints.
Joint venture formed in Mexico, Quimica Croda.
Croda expands printing ink operations in US with the purchase of Richardson Ink Co. of Chicago.
Croda buys J C Bottomley & Emerson, which makes dyestuffs and pigments.
Sir Frederick Wood once again takes over reins as Chairman and Chief Executive.
There
was a strong synergy between printing inks and Croda’s long established paints business.
“ “


The commercial doctrine of the day seemed to be the bigger and more diversified the company, the more resistant it would be to economic downturns, and therefore the greater its prospects of success. Indeed, this philosophy had served the company well in its transformation from a small, family run business to a multinational corporation, so by the second half of 1970, Croda was once again ready for further growth.
With the acquisition of United Premier in 1967, Croda had acquired a 48% interest in a group known as L&H Holdings, which made processed vegetable oils for use mainly in paints and inks. Croda purchased the remaining 52% and its two sites at Hull and Barking were integrated into the group to form the Processed Oils division.
In 1971, Croda made a further acquisition of A B Fleming (Holdings) Ltd, a loose collection of four fairly autonomous operations manufacturing printing inks, graphic supplies and synthetic resins. Whilst quite a departure from its other activities, the new companies had strong synergies with the adhesives already sold to the packaging industry and Croda’s thriving paints business.
Flemings also had a successful, well-established business in South Africa and this too fitted in well with Croda’s plans to expand in that country. This latest acquisition was a good example of the company’s acquisition and merger philosophy, combining areas of common ground whilst providing opportunities for expansion into the new fields that Croda was looking for.
The market was now so accustomed to Croda’s appetite for headline-making acquisitions that it was less aware of the number of organic growth and technological developments that were taking place. Food acidulant sales were expanding rapidly and a start was made on a new malic acid plant in Widnes. A new edible oil refinery was constructed at Barking to complement the existing Seatons plant in Hull.
1973 saw another flurry of purchases, including London Oil Medina, a leading distributor of edible oils for the bakery and food industries. Overseas, a printing ink factory was purchased in Holland followed by another in Milan, Italy. 1974 saw the formation of Croda France, headed by Dennis Crowley from Croda in the UK, and Croda Brazil, headed by John Hughes, formerly of Croda Canada.
Croda Japan was formed at Shiga, headed by Tony Chell, formerly one of Croda’s first management trainees. The company pioneered huge advances in refining technology with its unique Super Refining process, bringing new levels of product purity and quality, including the aptly named Snow White Lanolin. Fifty years on, the process is still one of Croda’s key global technologies in our pharmaceutical and Beauty businesses.
Whilst remaining as Chairman, Fred Wood handed over his Chief Executive responsibilities to Ernest Tyerman. Already well known to many Croda employees as head of the Polymers division, Ernest Tyerman was a classic example of progress from office boy to Chief Executive over a career that spanned 24 years.


By Noel (Nobby) Curley Formerly of Croda Chemicals
As one approaches the end of a working life, one remembers all the old friends who have gone before. Hubert (Young), Ted (Hughes), Bert (Taylor), John (Barnes), Frank (Banham) – and many more, too numerous to mention. Croda people. Croda has been my life. I have never regretted a moment of the time I have spent here, and never thought I would work anywhere else. Whilst at Croda, I’ve married, brought up children, who have brought up their own children. I still remember walking down the empty yard at Rawcliffe Bridge at four o’clock in the morning to collect my lorry to start the long day’s journey. The smell of the woolgrease ovens; the coal fired boiler with the boilerman feeding it by hand. I remember that first long distance journey – as a novice driver who had never travelled more than 50 miles from home. Two hundred and fifty miles to Port Talbot in South Wales, and no motorways. And then bumping into one of our own drivers, Eric Smith – boy, was it good to see a friendly face – who showed me around the giant steelworks there.
During those 18 years, those long days were to be my life, with fellow drivers Ken Maynard, Eric Smith, Jack Stones, Arthur Gelder, and later, Joe McGeever and John Lister. Every day holds a memory. In 1966, the day before England won the World Cup, I was on my way to Port Talbot again, with a batch of rolling oil, when at Monmouth the tanker caught fire. I had to leave it to be repaired and began ‘thumbing’ my way home. On the Saturday, the day of the final, the roads were deserted. When England scored that memorable, final goal, I was hitching a ride through Nottingham.
The annual pensioners’ dinner at Cowick Hall has always been a special time to meet old friends. I used to drive the bus and help with the bar. On one occasion, I was driving through Worcester, when one of the back wheels fell off the wagon. But Lady Luck smiled on me and I managed to hitch a ride home, just in time to get everyone on the bus in time for dinner. In time to share a memory or two with those friends and colleagues who dedicated large parts of their lives to building up this great company of ours.

I never thought I would work anywhere else. “ “
Away from the headlines of the City pages, various small and successful companies were absorbed into the group involved in a range of industries, from pet foods to dripping manufacturers, which, like an earlier foray into dried egg production, saw Croda entering new areas that were increasingly removed from its core businesses.
Meanwhile, in Australia, Croda’s operations were doubled overnight with the acquisition of the Lusteroid group of paint and printing ink companies. In 1975, the company took over Midland Yorkshire Holdings, which made synthetic chemicals, road tars and bitumens. It then expanded its metal treatment activities, buying the longestablished Doncaster-based company, Kenneth Thelwall & Co, which made blended oils and greases, mainly for the mining and automotive industries.
When Croda celebrated its 50th anniversary in 1975, it was a vastly different company from the one that celebrated its 25th anniversary in the Co-operative ballroom in Doncaster, and likewise, a far cry from the company that had gone public in 1964.

Profits had slowly but surely risen from zero to £230,000 in 1964 and, by 1974, in the order of £12 million. Some 6,600 staff manned 36 plants around the world compared with just 350 employees at four factories in 1964. Croda had not only grown faster than any other firm in the chemical sector worldwide over the previous 25 years, but was one of the fastest growing enterprises of any industry in the UK for the previous decade, thereby justifying the accolade that Fred Wood had awarded it some years earlier: ‘Croda – the fastest growing name.’
Investors and the financial press were impressed and Croda was ranked fourth in the 1975 Management Today British Business Growth League. However, 1975 profits went down for the first time in ten years, although this was not allowed to interrupt the company’s expansion programme and the takeovers continued –occasionally straying even further into unchartered waters for what was predominantly a speciality chemicals company. In 1977, Croda acquired Kimpton Brothers, which traded in spices, waxes and ethnic foods. Kimptons also included Manley Ratcliffe Ltd, which overnight made Croda the UK’s second largest retail supplier of honey, even embarking on a TV advertisement for its innovative ‘Honey in a tube,’ voiced by the well-known actor Richard Briers.


Returning to more familiar territory, this was followed by the acquisition of Thornley & Knight, which made specialised vehicle paints, and then in 1978, Croda expanded its printing ink operations with the acquisition of Chicago-based Richardson Inks. A year later it bought Brighouse-based J C Bottomley & Emerson, which made dyestuffs and pigments.


By the end of the decade, Croda had grown into a huge and diverse conglomerate. However, one former director had observed that Croda was beginning to find itself in businesses it did not truly understand. Whilst there was a ‘colourful’ synergy between say dyestuffs and its long established paint operations, and then the move into printing inks, conversely trading in spices and selling honey to the retail market was a vast departure from Croda’s usual sphere of activities – and expertise.
As seems to be a trait, the end of a decade often heralded a period of great change or transition for Croda, and this was to be no exception.

In 1979, Ernest Tyerman transferred to the role of Joint Deputy Chairman alongside Don Jackson, so Fred – by this time, Sir Frederick Wood (he was knighted in 1977) - once again took over the reins as Chairman and Chief Executive. But even with Sir Frederick back firmly at the helm, concerns about
Croda’s direction of travel were mounting, exacerbated by heavy increases in interest charges producing what were described as ‘unexciting results’ and little movement in share price. Croda – so often the predator, was about to become the prey…
There is a pleasing link with Croda’s former honey activities and the vital role bees have to play in their invaluable contribution to biodiversity at a number of Croda sites. One example is Sederma, where the team welcomed 40,000 bees along with their two hives to their new home on a lawn at the site, near a pond. Nine months later, the buzzy little bees produced their first honey harvest – an impressive 33kg! Similar activities have been established at other sites, including Rawcliffe Bridge, Croda Denmark and Croda Chocques.


During the early 1970s, Croda Way, the company magazine, featured visits by well-known TV celebrities of the day to different Croda sites where they met and chatted with employees working in different departments, including the offices, labs and production.
These included Esther Rantzen (Croda Wigan), Barbara Windsor (Luton), Margaret Powell (Oldham) and Una Stubbs (Widnes) and many more. After her visit to Widnes, Una Stubbs told Croda Way: “The bit I enjoyed most was the spaghetti machine which extruded long gelatin noodles – if only they would let me and my two children loose on that machine we could have tremendous fun!




1980
Croda expands Colours division with acquisition of Colne Vale Dyestuffs & Chemicals, followed by Frado BV, a Dutch manufacturer of sulphanilic acid.
1981
Croda opens new factory in Campinas, Brazil.
Burmah Oil makes abortive bid for Croda.
1983
Croda sells its Synthetic Chemicals business to the Royal Dutch/Shell Group.
1984
Croda purchases R Castelein & Co, a Belgian manufacturer of adhesives and sealants.
1985
Sir Frederick Wood hands over executive responsibilities to Mike Cannon, President Croda Inc.
Croda becomes first company to develop a wheat-based protein ingredient.
Croda sells its UK printing inks business followed by its Premier Oils business.
Croda purchases Richards & Appleby, a branded private label and contract toiletries manufacturer, followed by Kolmar Cosmetics and the Dutch soap manufacturer, Hilko.
1986
New regional office opened in Singapore.
Sir Frederick Wood retires and becomes Honorary Life President.
1987
Mike Cannon appointed Chairman and Keith Hopkins appointed Group Chief Executive.
Acquisition of firefighting chemicals business of John Kerr & Co, followed by Uniser SA (France).
1988
Foundations laid for the redevelopment of Rawcliffe Bridge factory.
1989



Despite the harsh economic climate, with profits on what Chairman Sir Frederick Wood described as a plateau, diversification continued, and the flurry of takeover activity that characterised the previous decade continued into the early months of 1980. The new Colours division was expanded by the purchase of a Dutch business, Frado BV, followed by Colne Vale Dyestuffs, a small firm based in Huddersfield.
The September issue of Croda Way, the company magazine, carried the headline ‘Hard Times’, reflecting the reasons behind Croda’s disappointing drop in profits for the first six months of 1980, exacerbated by the worst economic recession for many years.
Sir Frederick Wood addressed the situation with a three point plan focusing on improved sales and margins, reduced borrowing and a radical programme of spending cuts and cost reduction. Alongside the drop in profits, the share price fell, making Croda an attractive takeover target.


True to form, just before Christmas 1981, Burmah Oil bought 14.9% of Croda’s shares in a £12 million ‘dawn raid’ on the Stock Exchange, as a prelude to a full bid which, as expected, was announced shortly afterwards. From the outset, Croda’s Board was determined to resist the offer, which it felt was against the interests of its employees and shareholders. In the ensuing battle, Croda’s unusual and spirited defence employed the old maxim ‘The best form of defence is attack’.
A comparison of the respective track records of the two companies highlighted the fact that Croda would not be short of ammunition, reinforced by almost unanimous support from the financial press. For several weeks, blow was matched by counter blow, but thanks to a combination of factors, primarily a detailed and optimistic report on Croda’s future prospects, the pendulum began to swing in Croda’s favour. Burmah finally gave up its bid in March 1982.


A key factor in Croda’s defence strategy was the continuing loyal support of its shareholders. Even before the Burmah bid, the company had decided to ‘open its doors’ via an innovative approach to its Annual General Meetings. Moving away from the traditional hotel venues, Croda decided to give shareholders and employees an insight into various aspects of the company ‘in action’ by holding the meetings at different Croda sites in large marquees, accompanied by exhibitions, factory and laboratory tours, along with Open Days for customers and suppliers, schoolchildren and members of the local community. Visitors had the opportunity to see products and processes at first hand, whilst engaging with employees actually working at their respective jobs, whether in the plant, laboratories or offices.
The first such event kicked off at Croda Polymers, Harefield, in 1981 when the company focused on paints and printing ink manufacture. Subsequent events moved to Newark (Croda Adhesives), Berinsfield near Oxford (Manley Ratcliffe: private label honey), Ashby-de-la-Zouch (Standard Soap: private label soaps and toiletries), Luton (gelatin) and Croda’s global headquarters at Cowick Hall, which included a visit to its first-ever factory at nearby Rawcliffe Bridge. At the Cowick Hall event in 1986, shareholders were given a copy of that day’s Financial Times in which Croda had taken out a full page advertisement describing how its products formed an important part of other people’s end products.

Reproduction of full page advert in the Financial Times on AGM day, 30 May 1986
The legacy and lessons learnt from the whole Burmah episode forced the company to re-think its strategy of growing primarily by acquisition and of being a diversified conglomerate. It had meted out a harsh, but by now, somewhat familiar lesson: stick to businesses that you understand. Croda undertook a review of its operations and, after two decades of acquisitions, began to divest the parts that did not form part of its core strategy – but at the same time, continuing to invest in companies that would contribute to its future. And that future would be focused on what it had always been best at: natural-based speciality chemicals. Going forward, Croda would focus on those end-markets that showed good growth, such as personal care and household products. High value products for niche markets were the aim.
Despite being ‘non-core businesses’, many of the companies acquired over the years had benefited from considerable investment, with some, such as Standard Soap and Manley Ratcliffe, occupying leading positions in the market, enhanced by their extensive private label activities.
The growth and vigour of retailing in the UK confirmed the view that consumer products could still be a profitable area of expansion so, whilst somewhat outside of the renewed focus on speciality chemicals, Croda proceeded with a number of strategic acquisitions, including several private label and contract soap manufacturers.
However, in other areas, difficult decisions had to be made. An early casualty was Croda Synthetic Chemicals, whose products were subject to the vagaries of demand for a small number of littleknown commodity chemicals. Another casualty was Croda Foundry Chemicals based in Halifax. In 1985, Croda sold its UK printing inks business to Fishburn Printing Ink. With the crushing and refining of edible oils from oilseeds increasingly conducted in large-scale modern plants in the US and continental Europe, the Premier Oils operation became barely profitable and was sold to the major US concern, Cargill, in late 1985.

Stick to businesses that you understand. “ “
Bowmans Chemicals 1905

The original ‘Vat House’ pictured when Mr Bowman started his company in 1905. The photograph was kindly sent by Croda shareholder Mr J Calland, who recalled his time working at the Widnes factory: “When Mr Bowman died, we had a Managing Director called Mr Pert, who knew very little about the processes, but used to roam around and we called him ‘The Happy Wanderer’. If he spoke to me, I had to remove my cap, stand to attention and say ‘Sir’. He was a nice man and always left me with the same words: ‘Carry on working!’



Croda’s vegetable-based derivatives imparted the same beneficial characteristics as animal-derived products

Marketing insights, particularly from the US, indicated growing demand for the use of naturally derived products in cosmetics and toiletries, aligning with Croda’s sustainability credentials. For example, the discovery that adding a protein derived from silk to a hair conditioner made the hair ‘silky’ was significant – not just because the product performed well, but its origin enabled manufacturers to market their products as truly ‘natural’. In 1985, Croda became the first company to develop a wheat-based protein ingredient, imparting the same beneficial characteristics as animalderived products.
Some years earlier, Croda Universal had developed the technology to separate out Essential Fatty Acids known as omega-3 lipids from fish oil, which were found to have many beneficial effects on the brain and in the treatment of various skin complaints. Another group of Essential Fatty Acids are called omega-6 lipids, which are present in certain vegetable oils such as borage or evening primrose oil. These lipids have applications not just in cosmetics, but also as dietary supplements, for example to combat atopic eczema.
Using the same Super Refining technology developed by colleagues in Japan, Croda Universal used this process at its Leek factory to manufacture these exciting lipid derivatives, which were sold under the Incromega trade name. The team also formed a joint venture with CK Oil Crops Ltd to actually grow some of these new crops which would form the lipids of the future.

By Colin Prosser Managing Director, Croda GmbH,
During my time in Germany and in Europe, my memories encapsulate that special ‘spirit’ of our employees. Like every company, we had our fair share of problems, but it is how you pull together and react to them that matters.
1980-1997
At Kaldenkirchen, we saw an important aspect of our job as insulating the customer from any problems that might arise during production and delivery. No doubt a number of our staff there will remember the ingenuity of some of our warehouse staff in overcoming a problem with one particular product which, at that time, many years ago (but not now, I might add) was not that uncommon, namely oversize ‘conglomerates’ (i.e. lumps) in the product.
For one of our major customers, this would have created lots of problems had we released the product – but there was no time to manufacture a new batch. So, without fuss, in true ‘Blue Peter’ tradition, the guys in the warehouse quickly assembled an automatic shaker/sieve using a variety of old parts and components.
Then, the whole team, me included, quickly donned overalls and improvised face masks, and for the next three days, sieved our way through several tonnes of product.
A property of this particular product was to impart ‘slip’ to plastic surfaces, such as carrier bags, making them easy to open – and slip is just what they imparted. Everything and everyone in the warehouse ended up with a slippery coating so we were slipping and a-sliding all over the place! But the day was saved, the customer was happy (and none the wiser) - and we had managed to slip out of a tight corner, literally!
Of course, we couldn’t have got away with such an operation in today’s safety conscious environment, but thanks to the huge investments we have made around the group in quality improvement, Safety, Health and the Environment over the years, it’s no longer necessary.



As the decade drew to a close, however, the main focus was back to where it all began with a major capital investment programme to modernise and reconstruct Croda’s first-ever factory at Rawcliffe Bridge. This would encompass virtually all of the existing site plus seven acres of adjoining land.
This would not just be an investment in plant and equipment, however – it would be an investment in people, who have always been the beating heart of Croda, and none more so than at Rawcliffe Bridge with their strong family traditions and community spirit. People such as Hubert Young, a former works manager, who summed up those early, somewhat precarious years in his own, inimitable style when he said: “We had nowt – and shared it!”
The decade was also a memorable one in terms of personnel changes at the top of the company. On 1 April 1985, Sir Frederick Wood handed over his executive responsibilities to Mike Cannon. Some 30 or so years earlier, following Fred Wood’s return from the US to the UK, Mike Cannon had taken over the helm of Croda Inc, steering the US company to become one of the group’s fastest growing and most profitable operations. There was also a pleasing link with the past in that both his and Fred Wood’s fathers, Eric Cannon and A P Wood, worked together in the tiny factory at Rawcliffe Bridge some 60 years earlier. Sir Frederick finally retired at the end of 1986, becoming Honorary Life President, with Mike Cannon taking over as Chairman in January 1987.

Succeeding Mike Cannon as Group Chief Executive was Dr Keith Hopkins. Whereas most of his forebears had spent their whole working lives at Croda, Keith Hopkins had a strong academic background, gaining a first class Honours degree in chemistry at Hull University, where he subsequently gained his PhD. He had previously worked at Unilever, which was particularly useful to Croda as the two companies operated in a number of similar, parallel fields. This, aligned to his ten years’ experience in various senior management positions at Croda, made him ideally suited to his new role.

Two years later, in 1989, Mike Cannon announced his retirement and was succeeded as Chairman by Michael Valentine, who had been associated with the company for over 20 years. As a merchant banker with S G Warburg, he had advised Croda on all its acquisitions, as well as playing a key role in Croda’s defence strategy against the bid by Burmah. By bringing with him the power of Warburg’s, there is no doubt that he helped Croda to remain independent when so many other chemical companies were being taken over. As the decade drew to a close, the new partnership’s considerable knowledge and expertise in quite different, but complementary areas, would prove to be invaluable in meeting the challenges that lay ahead.
We had nowt – and shared it! “ “



The photograph (right), which appeared in the Hull Daily Mail in the early 1980s, was captioned ‘Hull’s industrial heartland’. Three of Croda’s Hull-based factories at the time can be clearly identified: (1A) Croda Premier Oils, Morley Street branch, extending along Stoneferry Road to the packing plant (1B).
On the other side of the River Hull lies Croda Paints (formerly Storry Smithson), Bankside (2).
The road winds alongside the river, eventually leading to the Seatons/Croda Processed Oils’ factory (3). Just out of view on the photo to the top right would have been Croda Universal, Oak Road, and Croda Premier’s Ann Watson Street branch.

Redevelopment of Rawcliffe Bridge site successfully completed.
Croda Universal at Hull develops Lorenzo’s Oil, which becomes the subject of a blockbuster Hollywood movie.
Croda buys Novarom, a German company specialising in botanical and herbal extracts.
Croda opens manufacturing base in Singapore.
Croda Hong Kong opened.
1994
Croda Nordica formed in Sweden.
Croda Poland formed to spearhead growth in Eastern Europe.
Croda India formed.
Sales office opened in Shanghai, China.
Croda Czech Republic formed in Prague.
Croda Hungary formed in Budapest.
New cosmetic proteins plant opened at Ditton, Widnes.
Croda buys the STOA group of companies in France, whose principal subsidiary, Sederma, is a world leader in active ingredients for skin care, including Matrixyl.
Croda buys the Westbrook lanolin business, making it the world’s leading supplier of lanolin.
Croda Ibérica formed in Barcelona, Spain.
Novarom merges with Phybiotex, part of the Sederma group, to form Crodarom, relocating to the Chanac site in France.
Michael Valentine retires, succeeded as Chairman by Keith Hopkins. Mike Humphrey becomes Group Chief Executive.
Croda Argentina formed.



Croda’s plan for the 1990s was a simple one: to concentrate resources and development on the area it knew best and had always been most successful: speciality chemicals, particularly those derived from natural oils and fats from renewable sources, thereby minimising harm to the environment.
The company’s biggest ever single investment at that time, the redevelopment of the Rawcliffe Bridge site, was successfully completed and officially opened by Chairman Michael Valentine in October 1990. A complete rebuild of a chemical plant whilst maintaining production was never going to be easy, particularly when it replaced long established, tried and trusted technology with new, state-of-the-art automated systems and radically new plant design.
Likewise, the learning curve for the technical and production staff was a steep one, requiring considerable retraining and learning new computer skills. With Croda’s typical ‘can do’ spirit, however, the whole team pulled together, underpinning the success of the project. The benefits were soon apparent, with reductions in raw material usage, higher throughput and, most importantly, reduced energy consumption and vastly improved environmental standards. While steeped in Croda’s past, Rawcliffe Bridge truly signposted Croda’s future.
It was apparent that for Croda to succeed, however, it also needed to further develop its overseas markets, reducing its dependence on the vagaries of the UK market. It is interesting to note that in the early days, like so many UK companies at the time, Croda sent UK personnel to head up overseas companies. As the outlook became more global, however, the preference shifted to appointing local staff to run these operations, generally resulting in better performance.
As well as developing those geographical areas where it was already successful, it decided to focus on areas where its core markets were expanding most rapidly, notably mainland Europe, the US and the Far East. Singapore was one such example. Croda had had a successful sales operation there for some years serving the ever-expanding South East Asian market.
With turnover steadily increasing and the abundance of valuable raw materials such as palm and coconut in the region, by the end of 1988 the time was ripe to establish a manufacturing base for its vegetable-based specialities. Environmental standards are high in Singapore so considerable negotiation with the various government departments was necessary throughout the project, but eventually, in April 1991, the new plant was officially opened.
“ “
While steeped in Croda’s past, Rawcliffe Bridge truly signposted Croda’s future.


As well as traditional vegetable sources such as coconut and palm, for some years Croda had been investigating the growing of alternative crops for the production of new vegetable oils. This research was carried out by the Croda Universal team in Hull, led by Keith Gregersen. Their Technical Director, Keith Coupland, presented a paper entitled ‘Fat is good for you’ to the Royal Society of Chemistry in which he looked at the role of dietary fat in the management of a number of diseases.
Harnessing Croda’s considerable expertise in omega-3 fatty acids, which are found in fish oils, attention was focused on omega-6 fatty acids. The body can process these materials into powerful antiinflammatory substances called prostaglandins. These fats, or lipids as they are commonly known, are not normally part of an everyday diet, but are present in certain plant oils.



It was this combination of expertise and dedication that would prove to be invaluable in producing Lorenzo’s Oil, a lipid derived from rapeseed oil which was used to treat Lorenzo Odone, who suffered from ALD (adrenoleukodystrophy), a rare and debilitating disease that affects young boys. This heart-warming story was to form the subject of a blockbuster Hollywood movie, starring Nick Nolte and Susan Sarandon. The Croda chemist, Don Suddaby, who delayed his retirement to create the oil, was actually cast in a cameo role as himself by the director, George Miller. “I told him I could never change the way I speak,” said Don in his distinctive Hull accent, “but he told me that’s just what he wanted for the movie!”


Croda growing
Expansion in Europe continued. Strengthening its natural credentials, Croda acquired the German company Novarom, which specialised in botanical and herbal extracts for cosmetics and toiletries.
Extracts of calendula or marigold flowers from Egypt, camomile from Hungary, mimosa from Germany and many others all exhibited their own distinct characteristics, offering tremendous potential for the creative cosmetic formulator. Unsurprisingly, the new range soon attracted considerable interest, particularly in the US where they were heralded as the basis of a new generation of personal care products with ‘natural appeal’.
Croda Nordica was founded to accelerate development in Scandinavia, followed by Croda Ibérica in Spain. Sales operations were set up in Poland, the Czech Republic and Hungary in anticipation of the rapid growth expected throughout Eastern Europe. In Asia and the Far East, sales offices were opened in India, Hong Kong and Shanghai in China.
Back in the UK, following on the heels of the redevelopment of the Rawcliffe Bridge factory, Croda continued to invest heavily in the Chemicals sector, the strategy being to improve existing products as well as introducing a stream of new products into the market. This was exemplified at the Leek factory where, using the same Super Refining technology developed for concentrating fish oil to produce omega-3 essential fatty acids, the facility was expanded to produce omega-6 fatty acids for the cosmetic and health care markets.
Investment continued at the Hull factory, increasing refining capacity for fatty amides, which are sold mainly to the plastics industry. A new cosmetic proteins plant was opened at Ditton, Widnes. The acquisition of the Westbrook Lanolin business made Croda the world’s leading supplier of lanolin.
Meanwhile, the non-core businesses of Manley Ratcliffe (honey), Cosmetics & Toiletries (Standard Soap and Richards & Appleby), Croda Bitumen (road tars and bitumens) and the remaining US printing inks business were sold off.
In 1997, Croda made its biggest-ever investment at that time with the purchase of the STOA group of companies, based in France. Its principal subsidiary, Sederma SA, is a leading business engaged in the development, manufacture and sale of active ingredients for skin, hair and scalp care.

It is the way these products are made that is so fascinating, for example using biotechnology to enable microorganisms to be used in the field of cosmetology. The names of some of the products made by Sederma – peptides, liposomes, ceramides, etc – are now almost as familiar to the consumer as the branded products in which they are incorporated.


The name of Matrixyl, for example, is perhaps the most wellknown and sought after ingredient in many leading anti-wrinkle preparations. It has helped to revolutionise the skin care market by taking proven anti-ageing benefits, previously available only in prestige products, and making them also available to everyday consumers who can buy products containing Matrixyl on supermarket shelves. Sederma has truly proved to be a jewel in the Croda crown.
From
Matrixyl has helped to revolutionise the skin care market. “ “

Another part of the STOA group was Phybiotex, located at Chanac in France. In 1998, Novarom, which was based in Germany, was merged with Phybiotex, transferring to the Chanac site. The new company was renamed Crodarom, its extensive range of botanical extracts perfectly complementing Sederma’s natural-based active ingredients and biotechnologies.
A decade earlier, Croda completed its largest ever investment at its Rawcliffe Bridge factory in Yorkshire. But the scale of that investment was soon to be overtaken as Croda turned its attention firmly to South East Asia, where, after a tumultuous period, the economy was bouncing back with a vengeance. Croda had already established a small manufacturing base in Singapore in the early 1990s, but its eyes were once again set on expansion and a large area of reclaimed land on nearby Jurong Island truly was a site to behold. The development of the Rawcliffe Bridge factory had been a steep learning curve for Croda, so what better way to harness the experience gained from that project than by combining the in-house team’s considerable know-how with the enthusiasm and technological expertise of the Singapore team – a combination that would welcome in the millennium by creating one of the most advanced chemical complexes in the world.
In fact, that experience was actually harnessed in an innovative and practical way. When the new alkoxylation plant was being built for Rawcliffe Bridge, an identical one was also constructed, destined for Singapore. Lessons learned during the construction process could be simultaneously applied to each plant. On completion, whilst the first plant was preparing for commissioning at Rawcliffe Bridge, its ‘twin’ was summarily deconstructed into transportable sections, then shipped out to Singapore, where it was rebuilt in a fraction of the time and with any potential pitfalls already addressed. It also brought the two teams together, acting as one throughout the whole process, knowledge sharing and forming friendships at the two Croda sites located at opposite sides of the world.


Palm Oil, an important raw material for Croda Singapore, is the world’s largest oil crop, with over 80% coming from Malaysia and Indonesia. Its wide use, particularly in food products, has attracted the concern of environmental groups. The high yield of the trees has led to the removal of forests in order to make space for oil-palm plantations, resulting in the loss of the natural habitat of the orangutan and other endangered species. As a result, the Roundtable on Sustainable Palm Oil (RSPO) was formed; a non-profit, multi stakeholder organisation dedicated to promoting sustainable production of palm oil worldwide.
Croda is an active member of the RSPO, working closely with its suppliers in order to source sustainable palm-derived raw materials that are certified in accordance with the RSPO Supply Chain Certification Standard. Following a comprehensive audit of systems and processes, Croda Singapore was the first Croda site to receive certification, with all relevant manufacturing sites subsequently certified.
In January 1999, there were further changes at the top of the company. Michael Valentine stood down as Chairman after almost ten years, with Keith Hopkins taking over as Non-Executive Chairman. Succeeding Keith as CEO was Mike Humphrey. Mike joined Croda as a management trainee in 1969 and over the next 28 years worked in most divisions in the group in a variety of roles. He was appointed to the Board in 1995, with responsibility for the oleochemical businesses in Europe and Asia, and had worked closely with Keith Hopkins in reshaping Croda’s strategic focus on speciality chemicals, including the acquisition of Sederma.

Croda was by now a very different organisation to the small family business started by A P Wood some 75 years earlier: a global leader in natural-based speciality chemicals. Its growth and evolution were characterised by creative, often visionary thinking, not just at the top, but throughout the company – attributes that would certainly be needed in abundance to meet the challenges of a new millennium.

Anyone for tennis… angling… cricket… golf… bowling…?
“ “
Health and wellbeing have always been paramount at Croda, as evidenced by the many ‘fun’ and sporting events that are now highlights of the global calendar, such as the Croda Vision Family Fun Day. The forerunner of many of these events was the Croda Sports and Social Club.
Over the years, the Sports and Social Club played a key role in the lives of Croda employees. Some were almost small businesses in their own right. At Hull, for example, the former ‘United Premier Recreation and Welfare Club’ had a full time steward who lived with his family in a house next to the club. Outside there was a football and cricket pitch, and a bowling green. Inside there were showers, changing rooms, snooker tables and a bar, and upstairs a concert room. And another bar.
Mike Smawfield, former Wages Manager at Croda Premier, was Club Secretary for a number of years and recalled being woken at two o’clock in the morning by the police. “A burglar had broken in through the roof, fallen and injured himself, so his accomplice had rung the police to come and get him out!” The club closed in the 1990s but the memories linger on.
It was the same at other Croda sites. Rawcliffe Bridge boasted one of the finest greens in the local bowling league thanks to Alwin Readshaw who, as well as being Sales Director at nearby Cowick Hall, was green keeper, Croda bowls secretary and midweek league captain. Alwin was part of the all-conquering Croda ‘A’ team of that era.




A new speciality chemicals complex is opened in Singapore – one of the world’s most advanced chemical manufacturing sites.
Croda celebrates its 75th anniversary.
Retirement of Chairman Keith Hopkins, who is succeeded by Antony Beevor, a former senior advisor in the London Corporate Finance division of Société Générale.
Death of former Chairman and Chief Executive Sir Frederick Wood, who had been the principal architect in transforming Croda from a small family firm to one of the world’s leading chemical companies.
Croda launches its 1% Club, giving employees paid leave to support neighbouring communities.
New North American Headquarters and Innovation Centre opened in Edison, New Jersey.
Retirement of Antony Beevor, who is succeeded by Martin Flower, formerly Chairman, Coats Plc, also Deputy Chairman and Senior Independent Director of Severn Trent Plc.
Enterprise Technology division formed, headed by Keith Layden, to identify and commercialise new technologies.
The first Croda Vision Family Fun Day is held at Cowick Hall.
Croda Greater China formed with offices in Hong Kong and Mainland China.
Croda acquires Uniqema from ICI, creating a chemical company with sales of almost £1 billion.
A wind turbine is installed at Croda in Hull, providing 40% of the site’s electricity.
Croda publishes its first sustainability report
Roger Jones Innovation Centre opened at Ditton, Widnes.
Croda India relocates to Thane site, formerly part of Uniqema.
Major expansion project begins at Cowick Hall headquarters, creating new offices, laboratories and a Customer Experience Centre.


Reaching the year 2000 was a milestone in all our lives. In his Millennium Message in Croda Way, the company magazine, Chairman Keith Hopkins said that 2000 was the year that Croda substantially completed the transformation of the group into a focused speciality chemicals company and one of the world’s leading companies in this field.
Threats such as the BSE crisis, which caused so many problems for the Colloids division at the end of the 20th century, exacerbated by the growing shift from photographic film to digital photography, forced the division to rethink its strategy, creating exciting new opportunities to exploit its world-leading speciality protein technology. An extensive range of vegetable-based proteins, amino acids and functional food additives was developed, offering customers viable alternatives to traditional animal derived products.
At Croda Leek, building on the increased awareness by the general public of the health benefits of dietary supplementation with fish oils, the company celebrated the new millennium with further investment in this area, with the aim of producing the highest purity lipids for the pharmaceutical and healthcare markets.
Of all the Croda sites, the one that had undergone the greatest change during the previous decade, however, was Rawcliffe Bridge. Old plants and processes had been swept away, replaced by computer-controlled process technologies installed to exacting standards, whilst upskilling the workforce to meet the challenges of the new millennium.
The year 2000 also marked the first stages of implementation of another major program and global team effort: SAP (Systems, Applications and Products in data processing), a software solution that brought together all of an organisation’s data in one place. The vision of the factory of the future was truly becoming reality.
And nowhere was there a better example of the factory of the future than Singapore, which heralded the new millennium with the commissioning of a brand new speciality chemicals complex built on a green-field site on Jurong Island. Croda developed the technology to separate out Essential Fatty Acids from fish oil and certain vegetable oils – products that are essential to good health and wellbeing


Croda celebrates 2000 was the year that Croda celebrated its 75th anniversary – and where better to celebrate than Rawcliffe Bridge, the home of its first-ever factory. The event, which was open to local residents as well as employees and their families, was split over three sites in the village. The local school playing field, just a few yards from the factory, housed a bouncy castle, fairground rides and a veritable feast of entertainment; from a brass band and dance troupe to judo demonstrations. A large marquee housed displays charting Croda’s history, with ‘join-in’ demonstrations for the school children, such as making bubble baths, creams and lotions with Croda ingredients.
Just over the road, the factory gates were opened and guided minibus tours gave local residents the opportunity to see at first hand the fruits of the site’s labours over recent years. The third centre of activity, attended by over 1,000 people, was at nearby Sugar Mill Ponds, where Croda and its partners, Groundwork Wakefield, English Partnerships and the Millennium Commission, had transformed an area of land and water from dereliction to beauty spot.
The end of 2001 saw the retirement of Chairman Keith Hopkins, succeeded by Antony Beevor, who had been on the Croda Board as a Non-Executive Director since 1996, and was a senior advisor in the London Corporate Finance division of Société Générale.
Sadly, in 2003, former Chairman and Group Chief Executive Sir Frederick Wood died after a long illness. From his appointment as Managing Director in 1953 at the age of just 27, for the next 30 years or so he was part of the fabric of Croda and principal architect in transforming what was then a small, local firm into one of the world’s leading speciality chemical companies.
The strategy to focus the business on high added value speciality chemicals resulted in the sale of Croda’s worldwide adhesives operations and withdrawal from its dyes and pigments business. Meanwhile, Sederma led the way in new product innovations, while Crodarom continued to push back the boundaries of ‘natural chemistry’ with a host of novel products extracted from plants using their own, unique microwave technology, which resulted in superior colour, odour and quality. Croda Personal Care launched lots of new speciality products, such as Keravis, an innovative new hair strengthening agent.

A major global investment programme included Croda Inc’s Mill Hall site in Pennsylvania, underpinning growth in the Americas, accompanied by the opening of a new facility at Edison, NJ, which brought together sales, administration and R&D in one building. Valuable new plant capacity was commissioned at Hull and Shiga in Japan. In Brazil, a new lanolin plant was opened – the only plant in Latin America capable of manufacturing low pesticide grade lanolin.
In 2004, Croda launched its 1% Club: a new way to help neighbouring communities. Employees were given paid leave (up to 1% of their annual working time) to spend time away from work and get involved in voluntary work in the community. One of the first, and some would say most inspirational examples, was Croda Hull’s Wendy Tattam, who used the 1% Club to allow her additional time to build on the success already achieved by the N.U.R.S.E Charity, of which she was Secretary, raising many hundreds of thousands of pounds through various fundraising activities to buy remedial and surgical equipment for the Hull and East Yorkshire Hospital’s NHS Trust and the local community.
Closer ties were formed with local schools, with mentoring schemes to help young people achieve their full potential; Enterprise Days to help pupils develop teamwork, communication and decisionmaking skills; and interview training with industry experts giving tips and advice through mock interviews. STEM (Science, Technology, Engineering and Mathematics) programmes were developed with hands-on activities and experiments to enthuse and inspire the next generation of scientists, engineers and innovative thinkers.

That same year, as part of an in-depth interview with CEO Mike Humphrey in Croda Way magazine, he presented his Vision for Croda. There were no surprises. Nothing was new or substantially different, or hadn’t been seen before in some shape or form, but ‘The Croda Vision’ brought it all together succinctly in a way that would be communicated to all employees worldwide. Multilingual inserts were printed to go in Croda Way, the company magazine. Coasters were produced displaying the key aspects of the Vision. The concept of the Croda Vision was actually devised by the firstever Leadership Development Group (LDG) - a team of senior managers from around the world - responding to a challenge from Mike Humphrey. They were then tasked with communicating the Vision globally.

reality throughout Croda.
One important aspect of the Croda Vision was: “We will remain a ‘fun’, lively, stimulating and exciting place to work, where all employees have the courage to question, and all functions and individuals are valued.” And so, the Croda Vision Family Fun Day was born, with intercompany and interdepartmental teams participating in an ‘It’s a Knock Out’ competition – with
Rawcliffe Bridge’s ‘Barmy Army’ competing against the likes of Croda International’s ‘Satsuma Wrestlers’ or the positively prehistoric ‘YabbaDabbaDoo’ team from Hull. Where you could end up in a foam bath with one of the senior directors, or bump into the Company Secretary on the bouncy castle – inhibitions were left at home making it truly a day to remember.
Ever since that first event, the Family Fun Day has been a key date in the Cowick Hall calendar, attracting increasing numbers of employees and their families from all parts of the UK. Spurred on by its success, Croda sites globally now hold their own equally fabulous annual fun days and events.


In September 2005, Martin Flower succeeded Antony Beevor as Chairman. Martin brought a wealth of experience, having held various senior executive positions with Coats Plc over 36 years, culminating in a period as Chairman.
That year also heralded a key appointment for an exciting new role within Croda. Keith Layden, formerly MD Personal Care and Health Care, Chemicals Europe, was appointed President, Enterprise Technology. The aim was to accelerate the company’s growth by identifying and introducing new technologies into the group, particularly in the core markets of personal care and health care. Generally, this was via three routes: looking for in-house opportunities; licensing third party technology, which is often linked to university research projects; or acquiring businesses and developing them.
Many of the fruits of Enterprise Technologies’ labours would not manifest themselves until some years later, but the seeds were already being sown. A review of Croda’s polymers business identified an obvious gap in the product portfolio, Acrylic Polymers, which provide rheology control or ‘thickening properties’. In just a few years, that gap would be filled at the Rawcliffe Bridge site.
The impending purchase of IRB, the global leader in plant cell culture, the first major acquisition managed by Enterprise Technologies, would lead Croda on the next stage of its sustainability journey. It may not have been apparent at the time, but Enterprise Technologies was already acting as a compass to steer Croda’s future direction.
“ “
Enterprise Technologies was already acting as a compass to steer Croda’s future direction.
From its earliest days, sustainability has been the cornerstone of every aspect of Croda’s business, its ‘natural chemistry’ based on mainly vegetable-based raw materials and an ongoing commitment to cleaner, safer and more energy efficient processes. But Croda’s environmental aims extend beyond its products and processes. Wildlife and conservation areas have been established at many sites globally. In 2006, with the help of local schoolchildren and employees, in conjunction with Woodland Trust, 25,000 trees were planted at the Cowick Hall headquarters, which, as they grow, are making a significant contribution to offsetting carbon emissions – a nice ‘twist’ for a chemical company.


For example, in Japan, running alongside the Shiga factory is the Uryu river, which runs downstream into Lake Biwa, the largest lake in Japan. The water is very pure, attracting many different species of fish and birds, including grey herons and white egrets, with their magnificent plumes. A major problem that affects the wildlife is the large amount of water weed, which can grow to such an extent that even the fish cannot penetrate it, so it needs to be removed periodically. Each year, usually in July, a team of Croda volunteers takes to the river to scoop out the water weed, often working from early morning to twilight. The result: a clean river – and a project that is greatly appreciated by the neighbours in the community (and the wildlife!).
For some time, Croda had been quiet on the acquisition front, buying just two ‘quality’ companies that fitted with its speciality chemicals strategy: Sederma and Westbrook Lanolin. That strategy had remained unchanged for many years - to be a leading, independent, global speciality chemicals company. Croda would only invest in companies operating in end markets that had long-term growth well above global GDP; that could create innovative technologies; and, most important, that shared Croda’s strong emphasis on sustainability.
Such companies were relatively few and far between, but at last one was found that met those criteria. A very special company that would not just create significant shareholder value, but would provide an exciting platform for future growth. That company was Uniqema, which was acquired by Croda in 2006.
Uniqema was a global manufacturer and supplier of oleochemicals, surfactants and functional ingredients, used in everyday products that improved the quality of life. Since 1999, it had operated as an autonomous and largely standalone business within the ICI group. The acquisition greatly strengthened Croda’s production capabilities, with manufacturing sites throughout Europe, North America and Asia. It also enhanced the product range, adding industry leading surfactants, as well as many other oleochemical specialities that were new to Croda.


By Graham Myers, former Group Financial Controller, Croda International
29 August 2006 will go down as a pivotal date in Croda’s history - although hardly anyone was there to witness this momentous event! It was the Tuesday immediately following August Bank Holiday Monday - a day when Cowick Hall is normally closed to celebrate Founders’ Day. However, on this particular Tuesday the site opened for the Extraordinary General Meeting at which shareholders approved Croda’s acquisition of Uniqema from ICI.
Whilst there were so few of us at the meeting, as nearly all votes were cast by proxy, those that were will always remember the enormous clap of thunder that sounded as the meeting commenced amidst a passing storm. Anyone superstitious might have worried, but they needn’t have as the acquisition proved to be key in transforming Croda into such a valuable business. It was so fitting the meeting was not only held on Founders’ Day, but that it also took place in the Cowick Hall canteen - fit for purpose and so very different from what everyone else might have done.
“

Cream of the crop
Through Uniqema, Crop Care quickly became one of Croda’s most important businesses. While Croda didn’t make the active ingredients for pesticides, the role of its products, mainly surfactants and dispersants, was to help the active ingredient carry out the task for which it is designed. For example, the surface of a leaf has a waxy-type coating that repels water, with the result that it drains off. The incorporation of Croda’s biodegradable adjuvants into the formulation allows the active ingredient to penetrate the leaf and do its job by improving the wetting characteristics of the formulation. Croda had already taken its first steps into sun filters through its Optisol range, but through Uniqema, it was thrust right into the heat of the sun protection market, adding an exciting range of truly transparent inorganic UV absorbers marketed under the Solaveil Clarus brand name. This was later extended further by the development of the SpeXtra range, which focused on protecting the skin from UVA radiation and reducing the ageing effects of sunlight.

Whereas the two transformational acquisitions (United Premier and British Glues & Chemicals) of some 40 years earlier had been hard fought and at times acrimonious, thanks to the efforts of CEO Mike Humphrey and the respective teams from Croda and Uniqema, under the leadership of Kevin Nutbrown, Croda’s President Operations and Global Manufacturing, the integration process was carried out with speed and efficiency, bringing to Croda some great people, superb technologies and a much more balanced geography.

Croda has always considered its non-financial metrics to be as important as its financial ones. With its passion for sustainability, in order to demonstrate its continuing commitment, in 2008 the company published its first sustainability report, formally setting out the reporting indicators that are still in use today. The aim of this, and subsequent reports, was to document Croda’s sustainability journey and its impact upon its business, customers and the wider world. It demonstrated progress towards its commitment to become Climate, Land and People Positive, whilst underscoring Croda’s ambition to become the most sustainable supplier of innovative ingredients.
There was no more visible evidence of Croda’s commitment to sustainability than the installation of a huge wind turbine at its Hull site, in the heart of the city, to reduce spiralling energy costs. Many issues had to be addressed to adhere to the strict planning conditions, not least reptile mitigation plans to avoid harming protected species during construction. A helpline was established to address any local community concerns. Eventually, all obstacles were overcome, and on 12 November 2008 - the culmination of a three-year journey - the new wind turbine was inaugurated by CEO Mike Humphrey. After just a few months, the turbine was achieving expected performance, providing approximately 40% of the site’s electricity.
As the decade drew to a close, Croda had offices and technical facilities in 36 countries and operated 19 state-of-the-art factories across Europe, Asia and the Americas. In those areas where Croda could no longer add value, it made disposals, reshaping the business to focus on those market sectors and products where it could add the most value for customers and shareholders.
The global sale force was now selling the full range of Uniqema products, taking them into new and better marketplaces under the Croda brand – and proving to be a very powerful combination. Croda was now a truly global company, with less than 7% of its sales in the UK. Its customer-focused business model, always prioritising quality of business over volume, had been the basis of its success for many years. The aim now was to increase this focus to create future success.


Since its acquisition by Croda in 1955, the interior of the Hall itself had undergone considerable remodelling to create office accommodation, although successive management had always ensured that this was carried out sympathetically, in keeping with the overall style and splendour of the building.
The various outbuildings around the site, their names often reflecting their former use – The Dower House, The Stables, etc – housed offices and, later, laboratories. With the growth of the company, particularly with the acquisition of Uniqema, it became obvious that a major redevelopment of those buildings was necessary in order to accommodate the additional staff, as well as expanding and updating the laboratories to create an Innovation and Training Centre.
As ‘the noughties’ drew to a close, work began on the project. Due to the historic importance of the site, it was carried out under archaeological monitoring. Excavations were to reveal a brick lined well, a substantial structure 1.60m in diameter with a depth of 6m. A brick sample from the well dated back to the 14th-15th century. Fragments of Humberware pottery were retrieved from the topsoil, all late medieval, possibly originating from the Cowick kilns, a timely reminder, if needed, that whilst signposting the future, the site was steeped in history.
And with the redevelopment of Cowick Hall, the foundations were similarly being laid for the next chapter in the Croda story.


Following an unbroken run of continuing sales and profit growth for over ten years, annual turnover hits over £1 billion.
The deaths of two Croda stalwarts: Mike Cannon, former Chairman and CEO, Croda International, and President Croda Inc, USA; and Edgar Lower, Croda’s first-ever Technical Director.
Sederma launches Matrixyl® synthe’6 for a visibly smoother and plumper skin.
Steve Foots, former President Croda Europe, appointed CEO following retirement of Mike Humphrey.
Croda joins the FTSE 100 Index of the London Stock Exchange. Croda Turkey formed.
Croda acquires the Italian company IRB (Istituto di Ricerche Biotecnologiche), the global leader in plant cell culture biotechnology. Official opening of the new Acrylic Polymers plant at Rawcliffe Bridge.
Croda acquires 65% equity interest in Sichuan Sipo Chemical Ltd (Sipo), a leading Chinese manufacturer of primary amides, novel fatty acids and speciality esters
Croda acquires Innovachem, adding Panthequat hair conditioner and LiquiWax cosmetic esters to the portfolio.
Croda acquires the speciality products business of Arizona Chemicals.
The ‘Global 100 Most Sustainable Corporations’ report ranks Croda as the UK’s most sustainable corporation and at number 25 in the world.
Launch of Croda’s new acrylic polymer, Volarest FL, for pharma and derma applications.
Croda acquires A M Coatings with its novel anti-microbial technology for coatings and adhesives.
Croda acquires J D Horizons, specialising in flow assurance chemicals for international oil markets.
Croda celebrates 50 years as a public company.
Chairman Martin Flower retires and is succeeded by Anita Frew. Croda acquires Incotec Group BV, (Netherlands), an innovative seed enhancement business.
Croda acquires Brazil-based Inventiva Ltda, with its advanced portfolio of encapsulation and delivery technologies
Atlas Point hosts ribbon cutting ceremony for the first US plant capable of producing 100% renewable, 100% bio-based nonionic surfactants – Croda’s largest ever investment.
Croda voted the most admired company in the Chemicals sector and 16th across all sectors of the UK economy in Management Today’s ‘Britain’s Most Admired Companies’ awards.
Croda acquires the Finnish company IonPhasE, a supplier of static electricity protection products.
Croda acquires Swedish research enterprise Enza Biotech to develop the next generation of renewable surfactants using carbohydratebased chemistry.
Croda purchases Plant Impact Plc, an innovative crop enhancement business.
Croda Health Care strengthened by the purchase of Denmarkbased Biosector, a leading global specialist in vaccine adjuvancy (subsequently re-named Croda Denmark).
Croda acquires Rewitec GmbH, a speciality lubricants company. Our Purpose is born: Smart science to improve lives™, spearheading Croda’s transition to becoming a truly Purpose-led company.


By 2010, Croda had delivered an unbroken run of continuing sales and profit growth for over ten years, with turnover hitting over £1 billion, despite the effects of a global recession. The acquisition of Uniqema in 2006 had been transformational, providing a platform for future growth, with an enhanced product range taking the company into new markets.
Going forward, the strategy was to streamline the business with tight cost controls, maintaining the focus on high value speciality products. But this meant difficult decisions had to be made. During 2010, the company announced the closure of its commodity oleochemicals factories at Bromborough in Merseyside, and Wilton in North Yorkshire, whose output was largely transferred to other Croda sites around the world.
The output of new and exciting products from innovation centres across the world continued to meet the ever-changing demands of the Personal Care industry. Sederma was once again at the forefront, with the launch of an exciting new member of its world-leading Matrixyl range. In the fight against wrinkles, Matrixyl® synthe’6 was the response, literally ‘filling in’ wrinkles from the inside, both on the forehead and crow’s feet, for a visibly smoother and plumper skin.
In 2011, Mike Humphrey announced his decision to retire from the company at the year-end, concluding 13 successful years as CEO and 42 years’ service with the company. In January 2012, Mike was replaced by Steve Foots, a member of the Croda International board. Steve joined Croda from York University in 1990 as a graduate trainee, following which he worked his way up the company to hold a number of senior positions, mainly in sales and marketing, in different areas of the business. He was appointed to the Croda Board in 2010. Prior to his appointment as CEO, Steve headed up the European specialities business, Croda’s largest division, and was a member of the Executive Committee.
With a strong focus on people, Steve’s priority has always been to ensure that Croda works as one global team. His vision was not dissimilar to that of his predecessor: to ‘grow the core’, focusing on niche, fast growing markets with differentiated, high quality technologies – but then, to move up a gear and take it to the next level. As if to signpost this commitment, that same year Croda joined the FTSE 100 Index of the London Stock Exchange.

Matrixyl® synthe’6 works with the natural structure of the skin’s matrix to produce a visible smoothing and lifting effect
My priority has always been to ensure that Croda works as one global team. “ “

The opportunity to meet those criteria came just one year later when Croda acquired the Italian company IRB (Istituto di Ricerche Biotecnologiche), the global leader in plant cell culture biotechnology. For the next stage of Croda’s sustainability journey, biotechnology would prove to be the perfect route, using nature itself to produce molecules, ingredients and products in a sustainable way. In order to maximise the potential of this exciting new technology, IRB was integrated into Sederma’s skin care actives business, alongside Sederma’s own extensive research into plant cell culture.
The purchase of the IRB business was the first major acquisition managed by Enterprise Technologies (ET). Indeed, the benefits of ET were beginning to really manifest themselves throughout Croda. At Ditton, again following what began as an ET initiative, the company invested in a multimillion pound bio-fermentation capability. This technology gave Croda access to low carbon, low energy and resource efficient methods, replacing multi-stage energy intensive processes. Along with the acquisition of IRB, Croda was now gaining access to novel products and processes not viable through ‘conventional’ chemistry.

Biotechnology uses nature itself to produce molecules, ingredients and products in a sustainable way.

Early career development, such as the Graduate, Industrial Placement and Apprenticeship schemes, has always been a key element of Croda’s ability to develop talent within the organisation.
The Graduate Program in particular has been a key highlight of developing leadership capability, with three of the current Executive Committee, including CEO Steve Foots, beginning their careers as Graduate Trainees in the UK.
Since the Graduate Program was launched it has been through many iterations, and currently, graduate development is offered to a diverse group of students across North America, Latin America, Europe and Asia.
The Graduate Program combines experiential, academic and practical learning opportunities to ensure support of people development at all levels of the company, and has been praised by representatives of the regional and often international relocations that the graduates experience. For example, in 2020, Croda graduates were instrumental in supporting the vaccine roll out of the Pfizer vaccine at the recently acquired manufacturing site in Alabama in the US.
Alongside these exciting developments in Personal Care, it was the Health Care business that was delivering the strongest growth in sales and profits. This was driven by the strong growth of the excipients business, selling into the pharmaceutical, dermatology and animal health markets. In drug preparations, excipients are everything else in the formulation that is not the Active Pharmaceutical Ingredient (API). Their important role is to solubilise, disperse, stabilise and deliver the active ingredient. Croda’s customers, which include all the world’s leading drug companies, place increasing importance on the quality, consistency and reliability of products to ensure that contamination is not introduced. This is where Croda’s high manufacturing standards give the company a real edge and strong reputation in the market. Another major part of the Health Care business was omega-3 ingredients, which are widely used in nutritional supplements. Research has shown that they play a crucial role in a whole variety of processes in our bodies and are particularly important for heart health. In 2012, Croda’s production facility at Leek was successfully inspected by the US Food and Drug Administration (FDA). This was an exciting development that meant omega-3 could be supplied into the pharmaceutical area.
Thanks to the operational capability of Croda’s GMP (Good Manufacturing Practice) site at Leek, it was able to manufacture a whole range of omega-3 products. From meeting simpler dietary and consumer health requirements through to fulfilling the most sensitive and stringent requirements needed to produce Croda’s first ever API – a pivotal moment in the development of the Pharma business.
There was more groundbreaking news (literally) at the Atlas Point site in Delaware, which had become part of Croda through the Uniqema acquisition. In 2012, the completion of a $6 million landfillgas-to-energy project meant that landfill gas from the nearby Cherry Island Landfill would provide enough energy to power 55% of the plant’s operations. This coincided with the site’s celebration of 75 years of continuous manufacturing and innovation, responsible for the creation of some of the chemical industry’s most wellknown emulsifiers such as the Spans and Tweens, which are still manufactured and sold under their original trade names as part of the Croda portfolio. A further step in the site’s sustainability journey followed two years later with a solar installation project, occupying 2.5 acres of the plant property, which would generate a further 5% of the site’s electricity.

An interesting aside to the Graduate Development story is that the forerunner of the Graduate Program was the Management Trainee Scheme, established in 1964, the year Croda became a public company The first ever intake comprised three young men. The youngest, and it has to be said, by far the most immature of the group at the age of just sixteen, straight from the local Grammar School in Goole, almost failed his probationary period – but was given a second chance, following a sturdy pep talk by ‘Mr Cressey’ (and, in all honesty, a few tears).
Luckily, our young trainee heeded the advice, put his head down and went on to train and qualify as an Analytical Chemist at ‘CRE’ in Snaith (the impressive sounding Croda Research Establishment) combining work and part time study for five years at Hull College of Technology. The Croda story is full of twists and turns - and this story is no exception. Having made some samples in the lab, the young chemist designed a set of hand-drawn labels for the jars of product. (This was pre-computers, of course.) At this time, Croda’s corporate image was confused with many variants, mainly as a result of acquiring lots of companies, each with their own identity. His designs impressed the Chief Chemist, who passed them on to the PR Director – none other than Mr (Stan) Cressey.
As a result, the young chemist was offered a total career switch to a new role of Group Design Manager, to work with Croda’s consultant designer to coordinate all aspects of group’s visual image - stationery, packaging, signing, etc. In turn, that led to a wider PR role, eventually becoming Head of PR on Stan Cressey’s retirement, reporting direct to Sir Frederick Wood – a keen advocate of a strong corporate identity. This also included editing Croda Way, the company magazine – a role that continued for 40 years.
Now, more than 60 years on, that former trainee is the writer of this book. Not a bad innings considering his Croda career was almost over before it started… on 31 August 1964.
By Alan Knights
Former Group PR Manager, Croda International, and Editor, Croda Way magazine, 1981-2021



My eternal thanks to Stan Cressey, who became my mentor and friend, for giving me that second chance!

If Steve Foots’ first year as CEO had brought lots of innovations and developments, the new year was to bring even more. January 2013 saw the official opening of the new Acrylic Polymers plant at Rawcliffe Bridge. As mentioned earlier, this was the culmination of Croda’s first ever major ET project, which came about when it was felt there was an important gap for these important polymers in the portfolio.


Acrylic Polymers have many effects across a variety of applications. In agriculture, for example, they improve dispersion and stability of active ingredients that are incorporated into the pesticides, herbicides and fertilisers that farmers use in the field to optimise their produce.
Farmers apply various crop protection products at the same time, saving multiple runs up and down the field on the tractor. Consequently, they need to mix them together in the tank with water, before spraying. This means keeping the crop protection products, often with different physical and chemical properties, highly stable under a variety of storage conditions and extremes of weather for long periods of time.
Acrylic polymer-based dispersants are able to stabilise the crop protection products so that they remain homogenous in the tank and do not separate out. Instead of all the products sinking to the bottom of the tank, they remain well dispersed so the farmer can be assured that all the crops are getting sprayed with the correct amount of product across the field.












To crown the year, the 2013 ‘Global 100 Most Sustainable Corporations’ report ranked Croda as the UK’s most sustainable corporation and at number 25 in the world. The report is compiled annually by Corporate Knights, a Canadian media organisation specialising in the area of corporate sustainability.
The following year, Croda celebrated 50 years as a public company. Perhaps one of the best indicators of success was that out of 32 chemical companies listed on the UK stock market in 1964, Croda was the only one still there – not only surviving, but prospering.
In September 2015, Chairman Martin Flower retired after what Steve Foots described as “an outstanding decade of growth and success for the group”. Martin was succeeded by Anita Frew, who was previously Deputy Chairman of Lloyds Banking Group.
Croda growing
In December 2015, Croda completed the acquisition of Incotec Group BV, an innovative seed enhancement business. Incotec products and services enhance and improve seed performance, allowing greater efficacy and functionality to be delivered directly by the seed to increase farming yields in order to feed the world’s growing population.

Croda was firmly back on the takeover trail, not just with IRB and Incotec, but also a host of smaller, strategic acquisitions. Meanwhile, the trilogy of Croda Personal Care, Sederma and Crodarom continued to push the boundaries of the consumer benefits that could be achieved with the incorporation of their natural-based actives and ingredients into personal care formulations. In 2015, Croda was announced the winner of the prestigious Supplier Innovation Award at the Global Brands European Supplier Conference hosted by Walgreen Boots Alliance. The accolade was to honour Matrixyl™ 3000 Plus – a new Sederma technology and powering force behind the hugely successful No7 Protect and Perfect Advanced Serum.
In Performance Technologies, the new Maxemul Polymerics capitalised on the trend to water-based coatings driven by evertighter environmental regulations restricting the use of Volatile Organic Compounds (VOCs). In Polymer Additives, Croda had firmly established itself as a global leader in slip, anti-static and anti-scratch solutions to customers in the premium packaging and automotive industries. Croda Home Care unveiled a new performance additive, ModiSurf Clarity. This breakthrough technology formed a protective layer on glass and polymeric surfaces, dramatically improving limescale repellency and reducing the tendency of glass surfaces to mist up. The wheels of Croda’s innovation machine rolled on relentlessly.
Croda Home Care’s ModiSurf Clarity imparts reduced misting and effective limescale repellence on glass and polymeric surfaces

Stretching the Growth: investing for the future
Alongside ‘Growing the Core’ by delivering consistent sales and profit growth, Croda focused on ‘Stretching the Growth’ - focusing on accelerating product innovation, investing in new technologies and increasing intellectual property.
With the opening of the Beijing Crop Care centre and Singapore tribology labs, Croda had 34 customer innovation centres globally, enabling the company to work more closely with local customers to meet their consumers’ needs. A series of the biggest organic capacity investments for many years included the creation of a global centre of excellence in solar protection; the expansion of global manufacture in Latin America and India; and increased bio-tech production in the UK.

At the Hull site, work continued on PACE, the major Polymer Additives Capacity Expansion project, whilst at Chocques in France, the successful commissioning of a new alkoxylation plant substantially increased the site’s production capacity, facilitating a quicker and better supply to European customers. Croda Singapore celebrated the opening of its new alkoxylation plant expansion, as part of its strategy to develop and supply innovative solutions to Asian customers.
But it was Atlas Point in the US where Croda’s largest-ever capital project was about to become reality: a state-of-the-art facility whereby the site could manufacture ethylene oxide, one of the most important raw materials used in large scale speciality chemical production, from a renewable source of bio-ethanol.
On 18 October 2017, Atlas Point hosted the ribbon cutting ceremony for the first US plant capable of producing 100% renewable, 100% bio-based non-ionic surfactants, enabling customers to remove petrol-based ingredients from their formulations. With the launch of the new ‘ECO’ range, customers would no longer have to choose between meeting their sustainability goals and delivering high performance products to customers. Now, they could achieve both.


In 2017, Croda was voted the Most Admired Company in the British Chemicals sector and 16th across all sectors of the UK economy in Management Today’s ‘Britain’s Most Admired Companies’ awards.
Croda Chair Anita Frew and Keith Layden, Non-Executive Director, are pictured accepting the award presented by Michael Heseltine (centre), former Deputy Prime Minister
By 2018, Croda was in full swing. If sustainability is at the heart of Croda, innovation is its lifeblood. R&D was supported through enhanced Open Innovation and Smart Partnering programmes. Open Innovation gave Croda access to chemists, biologists and agronomists in universities and specialist research laboratories. Smart Partnering saw Croda co-invest with industry technology leaders, including the opening of a state-of-the-art Centre of Innovation for Formulation Science at the Materials Innovation Factory at the University of Liverpool.
Biotechnology capabilities were further strengthened by the acquisition of Nautilus Biosciences Canada Inc, a technology-rich marine biotechnology company based in Charlottetown, Prince Edward Island, Canada.
Growth in Life Sciences had been boosted by the acquisition of Incotec, giving Crop Care a presence in seed enhancement. This was reinforced by the acquisition of Plant Impact, an innovative biostimulant technology that works alongside other crop protection products to increase quality, yield and shelf life of crops.
In 2018 the Life Sciences sector was further strengthened by a complementary acquisition in Health Care, with the purchase of Denmark-based Biosector, (subsequently renamed Croda Denmark), a leading global specialist in vaccine adjuvancy, a natural extension of Croda’s existing high purity pharmaceutical delivery systems portfolio. The significance of this acquisition would soon become all too evident.


Meanwhile, Croda’s sustainability programme continued to invest time and resource in order to have an overall positive impact on the environment and society. Croda had always prided itself on doing the right thing, and it was important to see how all of this could be channelled into the longer-term vision for the company.
In 2018, this was the topic at a Board and Executive Committee meeting during which it was identified that first of all there was a need to explain and vocalise just why Croda exists; looking beyond financial targets and focusing on ‘who we are as a company, what sets us apart from our peers, and what we give back to the world around us’. In a nutshell, answering the question: what is ‘Our Purpose?’
Our Purpose had to bring together all of those elements in a straightforward and succinct way that could be communicated to every employee worldwide. It was decided that the best way to achieve this was to draw upon the knowledge and know-how of the people who know Croda best – the employees themselves. To encourage participation, a competition was held, inviting all employees to submit their own Purpose statement. The winning statement perfectly embodied those criteria: Smart science to improve lives™.

By Steve Foots, CEO Croda International Plc
Following a routine annual feedback session at the Board meeting with Dominique Laffy, a senior partner at Egon Zehnder (a leading global management consulting company), she commented that Croda was a great company, with a great Board, “…but you are missing a Purpose,” she added. “A Purpose that can galvanise the organisation around a greater good!”
When I reflected on Dominique’s words that evening, I realised she was right. Our employees had embraced every aspect of our Vision statement, which summarises what we aspire to… what we hope to achieve in the future (it even inspired the annual Croda Vision Family Fun Day) – but Purpose would keep us focused on just why we exist… our core values – and then how we can instil those values into our whole culture.
In good old Croda tradition, rather than paying external consultants to help us with this, we decided to engage the services of the ultimate source of knowledge about all things Croda - our employees themselves!
So, we sent out an invitation to every employee to participate in a competition whereby they would write down in just a few words their suggestion for an exciting Purpose that we could all get behind.
We were overwhelmed by the response, with literally thousands of submissions from every part of the Croda world. At a Board and Executive Committee meeting, we went through them all, eventually selecting the one that we felt most accurately and succinctly summarised Our Purpose. The winner was Bryan Danek, our US Industrial Sales Director who, as well as receiving the accolade of winning the competition, received $5K to be donated to the charity of his choice.
“


And so, Our Purpose was born…
Smart science to improve lives™

Covid-19 pandemic: the global outbreak of coronavirus disease.
Croda acquires Alabama-based Avanti Polar Lipids Inc, an industry leader in drug delivery technologies. Enters agreement with Pfizer Inc to supply novel excipients used in the manufacture of a Covid-19 vaccine candidate.
Global Acts of Kindness initiative launches to support specific needs of local communities.
Croda launches its commitment to becoming Climate, Land and People Positive by 2030.
Acquisition of Iberchem, a leading global fragrances and flavours company, followed by the acquisition of Parfex, a Frenchbased fine fragrance business.
Croda Foundation launches, an independently philanthropic arm of Croda International whose goal is to permanently improve one million lives by 2030.
Acquisition of worldwide business activities of Alban Muller, a leader in the creation and supply of natural and botanical ingredients for the global beauty industry.
New innovation centre opened in Shanghai to work with customers in China and North Asia.
Croda Inc relocates to new office and Innovation Centre in Princeton, NJ. Newly expanded pharmaceutical excipients facility opened at Mill Hall, PA.
Sale of majority of Performance Technologies and Industrial Chemicals businesses to Cargill.
Health Care business rebrands as Croda Pharma.
Expansion continues in Latin America with opening of new Molecular Distillation plant in Brazil, increasing capacity and facilitating manufacture of highly purified grades of lanolin.
Croda Chair Anita Frew appointed as a Dame Commander of the Order of the British Empire in the New Year’s Honours list.
Acquisition of Solus Biotech brings bio-based ceramides to the Consumer Care business and bio-based phospholipids to the Pharma portfolio, along with a new biotechnology hub in the region.
Anita Frew retires after nine years as Croda Chair and is succeeded by Danuta Gray, who has held board positions across a range of sectors for the past 19 years.
Croda celebrates its centenary with a series of events at global locations.
One would normally look forward to the hopes and challenges of a new year and a new decade – but it soon became apparent that these were not normal times. In February 2020, out of the blue, literally, the heavens opened up and the Cowick Hall community and neighbours faced flooding on a scale never seen before in that area – almost the size of Lake Windermere in the Lake District, England’s largest lake. The Hall itself managed to escape the floods, but properties in nearby villages were flooded, with residents taking refuge in Snaith Priory Church – directly opposite the former vicarage that was Croda’s headquarters in the early 1950s.
Communities pulled together and, likewise, teams from Croda (many of whom were part of those communities) came together to help out in whatever ways they could. From volunteering at shelters for those evacuated from their homes, to filling sandbags, as well as donating clothes, essentials and money, including a donation from the company to the Flood Relief fund.
But just as the waters began to subside, everyone, almost globally, was faced with an even greater challenge: Covid-19. What happened next is well documented. It was hard to find rays of light in the ensuing darkness, but there were some. Just as with the floods, communities pulled together like never before, with great acts of kindness and cooperation. Croda’s global family similarly pulled together, just as any family would. The health, safety and welfare of employees was paramount, so new and different ways of working were introduced. Some continued to work at global sites, fulfilling valuable orders, developing new products, etc, whilst following any new and necessary procedures to ensure their safety.
Others worked from home, keeping day-to-day operations running. Necessity has always been the mother of invention. In order to personally stay in touch with everyone across the company, Steve Foots introduced regular new communications channels to give employees regular updates. Marketing teams organised online webinars in order to stay close to customers. Croda’s new STEM (Science, Technology, English and Maths) team developed digital resources and utilised social media platforms to engage with schools, parents and pupils.
The company followed this up with a global Acts of Kindness initiative, making funds available to support local communities, tailored to their specific needs, and therefore often quite diverse. For example, Croda Brazil worked with one of its key customers, Sinter Futura, to make and deliver 100,000 bars of soap to the 3,400 indigenous groups living in the Capoto Jarina reservation in the Amazon region. A world apart – literally - from a UK initiative in Hull gifting laptops and tablets to pupils undertaking home schooling during lockdown.
Nearby villages were flooded, but Cowick Hall itself managed to escape the floods


By Eduardo Bocatto Croda Brazil
Frequent hand washing is a simple, but effective way to help prevent the spread of Covid-19, so the donation during the pandemic of 100,000 bars of soap by Croda Brazil and one of its customers to the 3,400 indigenous groups living in the Capoto Jarina reservation in the Amazon region was greatly appreciated.
Following the donation, as a token of appreciation, the main leader of the Kayapos, Mr Raoni Metuktire, sent two headdresses to the senior management at Croda Brazil.
Living in such an enriched environment as the Amazonian rainforest means that the community is very much dependent on natural resources, with a deep and spiritual commitment to the land. They commonly use face and body paint to decorate themselves, and beads and feathers in headdresses and on various items of clothing to confer ceremonial flamboyance. So, the donation of these two headdresses to the senior management at Croda Brazil was of great significance as they are made only for special occasions and rituals that signify something particularly meaningful to them and their way of life.
The shape resembles their villages, that are circular or ‘arch-like’ in their layout, signifying a large wheel turning between the past and the present. The colours all have particular significance. Red means warfare or hunting; green represents the jungle or woods; yellow represents family life and agriculture; blue reflects the central square of their villages. The feathers are from birds used for the preparation of their food and never solely for the creation of the craftwork.
The headdresses are now proudly displayed at the Croda Brazil offices in Campinas, near São Paulo – a memento of reciprocal Acts of Kindness during those difficult times.



Their kindness was met with a very special token of appreciation.
Many governments around the world recognised that the chemical industry was a critical player in the fight against Covid-19. For Croda, this was its chance to put into practice its Purpose statement: Smart science to improve lives™. Life Sciences worked with the World Health Organisation (WHO) and pharmaceutical companies in the quest to find a vaccine treatment. Crop Care supported food retailers in keeping food on the supermarket shelves. Personal Care products containing Croda ingredients helped to boost emotional wellbeing. Many Home Care products were used to clean and sanitise hospitals, homes and offices around the world. Throughout industry, Croda products played a vital role, somewhat reminiscent of those early pioneering days almost a hundred years earlier, when Croda worked closely with the government to provide valuable resources to support a different kind of war effort.

These were transformational times for Croda, having engaged with everyone to define and then enact Our Purpose, whilst trying to stay on course during the Covid-19 crisis. But as well as global health challenges, there would be others to face in the future, not least climate change. In order to better understand and respond to these challenges, the Board and Executive Committee spent time with the Cambridge Institute of Sustainability Leadership in the UK. It was apparent that Croda could do more than just reduce its negative impacts – it could positively improve the world and society through the use of its



In 2020, Croda launched its commitment to becoming Climate, Land and People Positive by 2030. By stretching new sustainability targets, this would enable the company to continue its journey to become the most sustainable supplier of innovative ingredients. This commitment would underpin the company’s whole global strategy, ensuring that Croda’s Smart science and technology would help tackle some of the biggest challenges the world is facing through alignment with the United Nations Sustainable Development Goals (SDGs).
Climate Positive would see Croda enable more carbon to be saved than it emitted. With a focus on helping customers and consumers avoid carbon emissions through the benefits-in-use of products, Croda would also increase bio-based raw material usage, as exemplified by the recently opened plant in the US, whereby the site could manufacture ethylene oxide from a renewable source of bio-ethanol.
Land Positive would enable more land to be saved than is used to grow Croda’s bio-based raw materials. Croda’s innovative crop science would help agricultural customers to mitigate the impact of climate change and land degradation, increasing the availability of land suitable for growing crops, whilst helping farmers to increase yields and crop resilience.
People Positive would see the company focus on the contribution it could make to Good Health and Wellbeing, and Gender Equality, by promoting health and wellbeing worldwide. Through the Personal Care sector, 60 million lives would be protected annually from potentially developing skin cancer from harmful UV rays.
Through the Health Care sector, Croda would contribute to the successful development and commercialisation of 25% of WHO listed pipeline vaccines.
Another important aspect in the quest to become People Positive was Croda Foundation.

Croda Foundation was born to make a difference in a world where people still go hungry, basic healthcare needs are not met, and vital ecosystems remain under threat. Established in 2020 and solely funded by Croda, the Foundation’s impact to date has been farreaching and diverse. As of 31 January 2024, £4.4m has been committed in funding and 22.8 million lives have been sustainably improved via the Foundation’s project partners.
The Foundation is embedded in Croda’s culture, with employees not only responsible for nominating projects, but also voluntarily helping project partners on a case-by-case basis by providing their expertise and know-how, which has maximised the Foundation’s impact to date.
This is evident through the Foundation’s project with Instituto Amazonas (IA), a nonprofit organisation dedicated to protecting the cultural heritage, environment, health and wellbeing of indigenous populations in the Amazon. The Foundation’s grant resulted in 7,455 indigenous people in 11 tribes being taught modern agriculture techniques to improve yields. This impact was supercharged thanks to Croda’s seed enhancement business, Incotec, whose employees provided technical support to the tribes on the growing and storage of traditional corn seeds. Numerous other projects have been supported, including The Association of Women in Agriculture Kenya to support vulnerable mothers living in urban slums; and the provision of funds to rehabilitate existing water sources, drill new bore wells and install water hand pumps in Omoro District, Uganda.

Some of the people who benefited from Croda Foundation’s projects in Uganda.

By Keith Layden Non-Executive Director, Croda International, and former Chief Technology Officer
The Lorenzo’s Oil story, referred to earlier, was a key milestone for the company as it represents the origin of our now very significant Pharma business. The vision of Keith Coupland, the technical skill of Don Suddaby and the manufacturing competency of the Hull and Leek sites came together to produce a material that has benefited the lives of so many children who suffer from Adrenoleukodystrophy (ALD).
From this modest start, we have expanded significantly. We have grown our portfolio; from nutritional lipids to the development of our Super Refining technology and, more recently, added industry-leading vaccine adjuvants and lipid technologies to our range.
In the last few years, we have evolved from Croda Health Care to Croda Pharma, reflective of our position as a highly respected and important supplier to the pharmaceutical industry, supplying major multinational companies such as Pfizer, Astra Zeneca and GSK.
Our greatest achievement to date is undoubtedly our role in the Pfizer/BioNTech mRNA vaccine that played a critical role in combating the Covid-19 pandemic. In a wonderful example of teamwork between engineering, technical, manufacturing, regulatory and commercial teams, we helped to protect billions of lives globally.


The quest to find a vaccine treatment was a priority, aligning with the aim of building Croda Health Care into a broad drug delivery business on a global scale. The acquisition of Alabamabased Avanti Polar Liquids, an industry leader in drug delivery technologies, provided Croda with its perfect partner - and the ideal platform to enact this strategy.
During 2020, pre-acquisition, the Avanti team in Alabaster saw a dramatic increase in their project pipeline, driven by potential Covid-19 treatments.


In March of that year, BioNTech, a German biotechnology company, along with their partner, Pfizer, one of the world’s premier biopharmaceutical companies, approached the Avanti team to discuss ramping up production of the lipid-based delivery system under development to support delivery of the mRNA vaccine. The forecasted volumes were beyond the capacity of Avanti, and it was clear they would need a partner to manufacture the quantities required for a global vaccine.
They contacted Croda about the urgent scale up of a lipid-based delivery system for a Covid-19 vaccine. This was just two weeks into the UK lockdown when most people were adjusting to working from home, although manufacturing sites were still operational. It quickly became apparent that the opportunity fitted Croda’s skillset, with experience of scaling lipids at Leek. What followed, was a wonderful example of the Croda team, along with their new Avanti colleagues, pulling together; technical assessments, process development, site investments, securing new raw materials and overcoming the logistical headaches of shipping samples at -20ºC.
These focused efforts led to an agreement to supply lipid components into the Pfizer-BioNTech Covid-19 vaccine. CEO Steve Foots described this as his proudest moment in more than 30 years at Croda, whilst recognising that none of this would have been possible without the flexibility and commitment of the Alabaster and Leek site teams, and many more beyond. He added: “We should feel very proud that in the midst of the biggest medical crisis of a generation, the most important drug treatment was powered by the innovation and ingenuity of our employees, supplying four ingredients into the Pfizer-BioNTech Covid-19 vaccine. The speed and agility of our team allowed Pfizer to get to market first, launching in the UK in early 2021.”
This vaccine marked an early use of innovative mRNA technology, which is expected to drive future excipient growth well beyond Covid-19 in the prevention of other infectious diseases and treatments, including cancer. The acquisition of Avanti, plus the industry leading vaccine adjuvant business Biosector (Croda Denmark), also served to cement the position of Croda Pharma and the wider Life Sciences business as a high growth, high value part of Croda’s future success – a business that was now rivalling Croda’s long held leadership in Consumer Care markets.
Just as Avanti and Biosector had proved to be great additions to Life Sciences, Croda found the perfect fit for its Personal Care and Home Care businesses with the acquisition of Iberchem, a fragrances and flavours business. As well as featuring in the majority of consumer brands sold across the world, there is also a proven link between fragrances and people’s wellbeing.
Shortly afterwards, a second transaction in the high growth fragrance market was made with the acquisition of Parfex, a fine fragrance business based in South East France. Parfex creates fragrances principally for the premium personal care and fine perfumery markets, leveraging the natural raw materials that are available in the region. The combination of Iberchem and Parfex served to establish a new creative centre for higher value fine fragrances in the world capital of an industry that has been synonymous with perfumery since the 16th century.



Another aim was to strengthen the Beauty Actives portfolio, which was achieved in 2021 when Croda acquired the worldwide business activities of Alban Muller, a leader in the supply of natural and botanical ingredients for the global beauty business. This portfolio was further strengthened in 2023 with the acquisition of Solus Biotech, a global leader in premium biotechnology-derived active ingredients for beauty care and pharmaceuticals. Located in South Korea, Solus expanded Croda’s Asian manufacturing capability and created a new biotechnology R&D hub in the region.
In order to enable the Consumer Care and Life Sciences businesses to expand more rapidly, in May 2021, the company announced a strategic review of its Performance Chemicals and Industrial Chemicals (PTIC) businesses in order to establish what ownership structure would best serve this part of the business going forward.

Alongside Personal Care and the Iberchem fragrances and flavours business, the third arm of the newly formed Consumer Care sector was Home Care, where growth continued, reflecting an ongoing consumer focus on hygiene, as well as new sales from its innovative fabric care ingredients.
Following the review, it was decided to sell the majority of the PTIC businesses to Cargill, with the retained activities forming a new Industrial Specialities sector, providing critical support to the Consumer Care and Life Sciences sectors in areas such as smart formulations, fibre and fabric, and water. In many ways, the sale marked the end of an era – but the beginning of a new chapter for Croda.
Another new chapter began in 2024 with the retirement of Anita Frew after nine years as Croda Chair. The previous year, Anita received a Damehood in the New Year Honours’ list, recognising her services to business and the economy. Anita was succeeded by Danuta Gray, who has held board positions with a number of the UK’s leading companies across a range of sectors for the past 19 years, most recently as Chair of Direct Line Insurance Group.

And so, we approach the end of our centenary journey, a journey that began at Rawcliffe Bridge in Yorkshire when Croda’s first manager, A P Wood, laid the foundations of a global business he could hardly have dreamt of. Throughout that journey, there have been milestones and memories, constants and commitments from which Croda has never wavered. A reliance on natural based raw materials, right from the early days of refining woolgrease to make lanolin, to producing the industry-leading ECO range of 100% renewable, 100% bio-based surfactants, enabling customers to finally remove petroleum-based ingredients from their formulations. A wheel of innovation that has never stopped turning, such as in sun care where the lines between sunscreens and skin care, and then skin care and colour cosmetics, are becoming increasingly blurred, giving rise to the emergence of new, hybrid formats – or as Croda describes it, the ‘Sunification’ of skin.
A focus on Prejuvenation rather than just rejuvenation – the latest skincare trend amongst Gen Z which aims to prevent the signs of ageing before they even appear. The perfect platform for Croda products that protect the skin from external aggressors such as UV rays and pollution. Actives such as retinol, peptides and collagen boosters that work to counteract early signs of ageing.
A commitment to continual improvement that has led to purer, cleaner and safer products, increasingly utilising the sun and the wind to provide power to manufacturing sites, ever mindful of the commitment to be Climate, Land and People Positive by 2030.
A customer-focused strategy: finding out their needs and working with them to fulfil them - just as A P Wood had done one hundred years earlier with his handwritten mailshots to prospective customers. Applying Smart science to help customers deliver on their own consumer and sustainability commitments, contributing to a better world for everyone.
In the workplace, building on the family ethos that has always existed. No longer a small family but one that has grown to become a global family bringing Croda’s businesses to life.
Commitments and obligations that don’t just extend to stakeholders, but also to the communities in which Croda operates – and then, through initiatives such as Croda Foundation, to those sometimes far-off communities that simply need some help.
In short, looking back at our truly amazing journey - but focusing on who we are today and the kind of business we have become, with an incredibly powerful Purpose.
And that Purpose is to use Smart science to improve livesTM .


A final word
Our centenary is first and foremost a time to celebrate. Our founding fathers would have been so proud to see how our small family firm has evolved into a global, multibillion pound business. Throughout 2025 there will be celebrations at all our locations around the world, large and small.
But it is also a time to reflect. Many of our core philosophies from the early years in Croda still hold true today. Our job is to supply thousands of products to thousands of customers, ever more internationally, with Asia now nearly as big as Europe and the USA. We do this through our innovative and entrepreneurial spirit, meeting customers’ unmet needs with patent protected products wherever possible. Often our ingredients are used at small inclusion levels, but critical to the performance of our customers’ finished products.
We will also continue to sell smaller volumes at higher value. In 1925, we built our first factory at Rawcliffe Bridge selling lanolin derivatives for hundreds of pounds for a tonne of material. This year we will open our new Pharma ingredients factory in Lamar in the USA, selling lipids for many thousands of pounds for a gramme of material.
If I have learned one thing from our great past it is all about relentless innovation and constant investment, and our biggest asset in delivering this is through the great people that work for Croda today.
Going forward, we will keep on doing the right things – just as we always have. That’s why we have been voted Britain’s Most Admired Chemicals Company – the longest-running peer review survey of corporate reputation in the UK - for the eighth year running. Most notably, the awards recognised us for our long-term value potential, rating Croda second out of ALL UK companies! A remarkable feat and a testament to the unwavering ‘can-do’ spirit and hard work of our employees.
2025 is not just a celebration of our first hundred years, it heralds the next step in our journey. We look back with interest and affection - but look forward with anticipation and enthusiasm. We are emerging as a very different looking business, more focused and ready for another period of exciting, innovation led growth.


“
Everything I see in our business underpins my confidence in our strategy –and our future. So, fasten your seat belts – that was just the first part of the journey… we’ve still got a long way to go… Onwards and upwards!
“
We create, make and deliver speciality chemicals that industries and consumers worldwide rely on every day.
Established in 1925, we have built a legacy of innovation, customer focus, and a forward-thinking approach that sets us apart.
Our Purpose, using Smart science to improve lives™, drives everything we do. With a team of over 6,100 passionate employees operating across manufacturing sites, laboratories, and offices globally, we harness cutting-edge science to develop sustainable solutions for unmet needs.
Collaboration is at the heart of our success. By working closely with customers and leveraging the expertise of our unified global team, we continually push boundaries, rethinking challenges to deliver innovative and sustainable solutions.
As a trusted partner across diverse industries, Croda is committed to enhancing everyday life while safeguarding our planet’s future. Whether it’s in beauty and personal care, pharmaceuticals, crop care, or industrial applications, we are proud to play a key role in shaping a better tomorrow through Smart science.
We are a focused Life Sciences and Consumer Care company. Our Smart science is found in products that touch our lives every dayfrom life-saving pharmaceuticals and sun protection, to crop yields and seed enhancement.
Consumer Care brings together the businesses within Croda that sit closest to consumers, using our Smart science to provide innovative and sustainable solutions to manufacturers in home care, beauty and personal care, and fragrances and flavours. Our knowledge, expertise and products enable us to offer formulations tailored to consumer demands across the world.
We help customers worldwide by providing the highest quality health care solutions, protecting crops and enhancing seeds. With a growing range of technologies aligned to global health and crop sustainability needs, we work to be a high value-add provider to customers.
Our retained business in Coatings, Textiles and Fibres, Water Treatment and certain other niche industrial markets are served by Industrial Specialities, supplying essential formulation ingredients and sustainable solutions from key Croda manufacturing sites across the globe.
We are a global company with operational locations specifically chosen to enable close customer working. We constantly invest in existing markets and expand into new ones to provides our customers with the most focused and responsive service.
The region has 11 offices including the regional headquarters in Singapore, nine manufacturing sites and nine R&D laboratories.
Australia
Greater
Our global headquarters are based in Yorkshire in the UK. We also have a number of offices and manufacturing sites spread across the region.
Denmark
Ethiopia
France
Germany
Italy
Kenya
Netherlands
Poland
South Africa
Spain
Sweden
Tunisia
In Latin America, we have a manufacturing site in Campinas, Brazil and six other sales offices within the region.
Argentina
Brazil
Chile
Colombia
Mexico
Peru
Turkey
United Arab
Emirates
United Kingdom
Croda Inc is our North American headquarters, with four manufacturing sites, four innovation centres and four sales hubs in the region.
Canada
USA
George Crowe 1926 – 1954
Sir Edward Crowe 1954 – 1960
Sir Frederick Wood 1960 – 1986
Mike Cannon 1987 – 1989
Michael Valentine 1989 – 1998
Keith Hopkins 1999 – 2001
Antony Beevor 2002 – 2005
Martin Flower 2005 – 2015
Dame Anita Frew 2015 – 2024
Danuta Gray 2024 –
A P (Philip) Wood 1925 – 1949
Sir Frederick Wood 1953 – 1973
Ernest Tyerman 1973 – 1979
Sir Frederick Wood 1979 – 1985
Mike Cannon 1985 – 1986
Keith Hopkins 1987 – 1998
Mike Humphrey 1999 – 2011
Steve Foots 2012 –
January 2025
Danuta Gray Chair
Steve Foots Group Chief Executive
Jacqui Ferguson Senior Independent Non-Executive Director
Ian Bull Non-Executive Director
Robert Cirillo Non-Executive Director
Chris Good Non-Executive Director
Julie Kim Non-Executive Director
Keith Layden Non-Executive Director
Nawal Ouzren Non-Executive Director
John Ramsay Non-Executive Director
Tom Brophy
Group General Counsel, Company Secretary and President Sustainability
Steve Foots Group Chief Executive
Sandra Breene President Consumer Care
Tom Brophy Group General Counsel, Company Secretary and President Sustainability
Dave Cherry Interim President Life Sciences
Anthony Fitzpatrick Interim Chief Financial Officer and President Strategy, Corporate Development and Industrial Specialities
Michelle Lydon President Human Resources
Mark Robinson President Operations
Designed and produced by Dawson Design
The author gratefully acknowledges the contributions of the many people, past and present, who helped to compile this book, in particular Sir Frederick Wood and Stan Cressey (‘Croda: the fastest growing name’: The first 50 years), Jim Simpson (‘Croda: a special chemistry’), John Killeen (‘A short history of Cowick Hall’).
Former CEOs Keith Hopkins and Mike Humphrey; Keith Layden, Dave Cherry, Sarah Saxelby, Chris Sayner, Julie Ross, Debbie Hill, Helen Prince and Catherine Dines; the contributors of the ‘Memories’ (some, sadly, no longer with us, but always remembered); and in particular, CEO Steve Foots and Sandra Breene for their continued support for the old(er) guy.
All personal data processed in the publication of this book is based on the legitimate interest of Croda and the publisher in promoting and celebrating the achievements of Croda and its personnel.
Further information can be found in the Croda Employee Data Protection Notice.
©2025 Croda International Plc